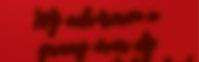

Henriëtte















































Ik betrap mezelf er de laatste weken steeds vaker op. Het voelt een beetje als spijbelen, stiekem, beetje slecht, spannend en tegelijkertijd ook heel leuk. Wat ik bedoel? Dat ik even wil ontsnappen aan de donkergrijze
wolk met ellendig nieuws, met nieuwe dreigingen. Even weg van de energiecrisis, de asielcrisis, de klimaatcrisis, de stijgende armoede, de hoge inflatiecijfers, de personeelstekorten, het dubieuze WK in Qatar….
Dus kijk ik ‘s ochtends om half 8 als de rest van het gezin al naar werk en school is, lekker nog een aflevering van The Crown voordat ik aan het werk ga of lees ik tussen
Op de plek waar de nieuwe woonwijk Blom komt, zijn de eerste bewoners op woensdag 19 oktober al welkom geheten.
Wethouder Van Waveren ont hulde samen met enkele leden van de werkgroep Wonen en Voorzieningen en de Ont wikkelcombinatie Novaform - Gebrs Hooghwerff het insectenhotel. Het insectenhotel duidt de bouwlocatie
en laat zien waar Blom voor staat: wonen met respect voor mens en milieu. De wijk wordt klimaatadap tief ingericht. Er komen twee grote wadi’s die ervoor zorgen dat bij regen het water op een natuurlijke manier wordt opgevangen. Rondom de wadi’s zijn de bomen en het groen bestand tegen zowel overtollig
de middag bij mijn broodje ook nog 3 hoofdstukken van dat mooie boek. Vorige week heb ik- geheel tegen mijn principes, want normaliter kopen we geen Sintlekkernijen voor de intocht- een grote zak kruidnoten gekocht én opgegeten en toen het tussen de regenbuien droog werd, heb ik mijn wandelschoenen aangetrokken en ben ik de polder in gegaan om een uurtje te wandelen. Alleen het ruisen van de bladeren bereikte mijn oren, geen verhitte
discussies in talkshows… Noem het struisvogelpolitiek bedrijven, dit gedrag van mij. Maar jeetje, wat knap ik er van op! Even alle actualiteit achter je laten en in je eigen bubble duiken voor een half uurtje. Daarna is de accu weer helemaal opladen. En natuurlijk probeer ik ook mijn steentje bij te dragen. De zonnepanelen zijn besteld, ik pak minder vaak de auto, douche een minuutje korter en heb besloten niet naar het WK te gaan
kijken.
Herkent u het gevoel? Dat je bijna saggerijnig wordt van al die nare berichten? Ik laat het niet meer gebeuren. Als het allemaal te grauw en grijs wordt om me heen, dan spijbel ik een half uurtje en geniet! Voor u ligt een Hoeksche Waard Exclusief met heel veel positieve verhalen van enthousiaste Hoeksche Waarders. Tezamen zorgen zij voor enkele uurtjes leesplezier. Geniet ervan!
water als tegen droogte. Het open baar gebied in Blom zal bestaan uit een mix van gazon grassen, ruige bloemrijke graslanden en gebieden met heesters/struikgewassen. Dit zorgt ervoor dat een groot scala aan dieren hier schuilplekken, nestplek ken en eten vindt.
Fase 1 van Blom, bestaande uit 31 woningen, gaat naar verwachting einde van dit jaar in verkoop. Alle woningen worden ten minste uitgevoerd als een zogenaamde energie neutrale woning. Alle eengezinswoningen worden zelfs uitgevoerd als nul-op-de-meterwoning. Dit houdt in dat de woning over het jaar heen voor woning gebonden gebruik (verwarming, warm water) én normaal huis houdelijk gebruik (apparaten, verlichting etc.) net zoveel energie verbruikt als dat er door de woning wordt opgewekt. Op de platte daken van de bergingen wordt een sedumdak aangebracht. Dit zorgt voor het vasthouden van regen water en trekt een variëteit aan vogels en insecten aan. De houten bergingen krijgen een regenton die is aangesloten op een grindkof fer, zodat regenwater gebruikt kan worden om de beplanting in de tuin van water te voorzien. Het hemelwater van de woningen en het omliggende terrein wordt niet op het gemeentelijk riool aangeslo ten maar zal uitlopen op de wadi’s in het middengebied.

Door de vormgeving van dit pro jectbord met natuurlijke materia len en als insectenhotel dragen we bij aan biodiversiteit en natuurin clusiviteit, nog voor het starten van de bouw van Blom. In Blom woon je ruimtelijk en groen, met hart voor de natuur. Blom is een ontwikke ling van Ontwikkelcombinatie Gebr Hooghwerff en Novaform Vast goedontwikkelaars
Meer informatie en aanmel den voor de nieuwsbrief: www.blom-klaaswaal.nl

Geen struikelstenen in OudBeijerland, schreven we in de oktober-editie van deze krant, eenvoudigweg omdat niemand er in deze gemeente het initiatief voor heeft genomen. Maar dat ligt toch wel wat genuanceerder zegt de Historische Vereniging Oud-Beijerland, die vindt dat er juist in het Spuidorp veel aandacht is voor wat de Joden in WOII is overkomen.
Omdat het deze maand 80 jaar geleden is dat veel van die Joden werden weggevoerd, heeft de Oudheidkundige Vereniging ‘Het land van Strijen’ tot eind dit jaar in het museum aan de Kerkstraat een expositie ingericht waarin veel wordt verteld en getoond over de Joodse families die in 1942 vanuit Strijen werden weggevoerd en werden vergast in de kampen Auschwitz en Sobibor. En er is ook volop aandacht voor de zoge naamde ‘Stolpersteine’, waarvan er in 2016 drie in Numansdorp en een jaar later 15 in Strijen zijn ge plaatst. De struikelstenen zijn een project van de Duitse kunstenaar Gunter Demnig.
Ook in Oud-Beijerland zijn er
gesprekken geweest over het aanbrengen van struikelstenen in deze gemeente, vertellen voorzit ter Pieter Jan in ‘t Veld van de Historische Vereniging en Alie van den Berg, auteur van het boek ‘Het Joodse verleden in OudBeijerland’. Maar Oud-Beijerland heeft al een Joods monument, ‘Am j’Israel Chai’, aan de Bierkade, op de plek waar de verdreven Joodse gezinnen op de tram stapten om nooit meer terug te keren. En in de wijk Spuioever zijn straten vernoemd naar Joodse families die hier voor de oorlog woonden. Zo is de Koopmanstraat in die wijk vernoemd naar de familie Koop man, die in het statige pand aan de Beneden Molendijk 29 de ‘bank van Koopman’ had; Hartog (53) en Helena (53) Koopman en hun drie kinderen werden in 1943, geeft het straatnaambord aan, in Sobibor omgebracht.
Dit alles bij elkaar én de jaarlijkse herdenking bij het Joodse monu ment op 4 mei, én het boek dat Alie van den Berg schreef, het zou wat teveel van het goede worden, om daar ook nog struikelstenen aan te voegen, meent de Historische Vereniging Oud-Beijerland.
Technische realisatie: Het Mediacentrum - Pijnacker • Druk: RODI Rotatiedruk, Diemen Bezorging/bezorgklachten: Bouwman Reclameverspreiding - Hellevoetsluis • Tel. 0181-315950 • info@bouwman-reclame.nl



















Zoals de makelaars van Makelaardij de Jong bezig zijn om op een professionele manier de hoogst mogelijke koopsom te realiseren voor onze verkopers en het in opdracht van diverse opdrachtgevers maken van taxatierapporten voor de financiering , zo zijn wij van de Backoffice bezig om alle processen rondom de verkoop, de aankoop, nieuwbouw en de taxaties in goede banen te leiden.
Wist u dat voor een transactie gemiddeld 160 contactmomenten nodig zijn?








Deze contactmomenten bestaan uit telefoontjes en e-mail berichten alsmede uit persoonlijke gesprekken met verkopers, kopers, notarissen, instellingen zoals het kadaster, milieudienst Zuid Holland Zuid, Bureau afgifte Energiecertificaat, banken, taxatiebureaus, hypotheekadviseurs alsmede het agendabeheer etc.

Daarom kunnen we met een gerust hart zeggen dat iedere klant bij Makelaardij de Jong in professionele handen is, gesteund door een team van jonge en enthousiaste mensen.

der Meijde hebben
Je vindt er keukens in alle soorten, stijlen en maten. Of je nou de voorkeur geeft aan een landelijke, traditionele, authentieke of juist een strakke, moderne keuken, bij Image Keukens in Oud-Beijerland bieden ze voor elk wat wils. De uitgebreide collectie bevat keukens voor de kleinere portemonnee tot exclusieve, op maat gemaakte keukens. En dat al een kwart eeuw lang. Het 25-jarig bestaan werd vorige week gevierd met relaties, leveranciers, familie en bekenden. Voor Hoeksche Waard Exclusief aanleiding om Image Keukens uit te roepen tot Ondernemer van de maand november.
Image Keukens zit al weer elf jaar aan de Willem-Beukelszstraat 4, naast de Gamma op woonboulevard De Bosschen in Oud-Beijerland. Directeur Jeroen van der Meijde zat daarvoor met zijn keukenbedrijf 14 jaar naast Leen Bakker op hetzelfde winkelplein. Omdat zijn bedrijf een gestage groei doormaakte, moest hij wel naar het grotere en meer in het zicht liggend pand verhuizen.
De showroom van Image Keukens (1000 vierkante meter, verdeeld over twee verdiepingen) mag er zijn. Keukens van de Duitse merken Schüller, Rotpunkt en Schmidt, die tegen het topsegment aanleunen, staan er in een huiselijk sfeertje. De laatste weken zijn er ook nog nieuwe modellen geplaatst. “We hebben bewust gekozen voor een ruime opstelling. We hadden er zo tien keukens meer in kunnen plaatsen, maar we willen de huiselijke sfeer benadrukken,” vertelt Van der Meijde.




Dat de zaken goed gaan, zelfs in coronatijd, is verklaarbaar, vindt hij. “Kopen bij Image Keukens staat voor zekerheid,” prijst de van oorsprong uit Rotterdam komende en tegenwoordig in Numansdorp wonende Van der Meijde (58) zijn bedrijf aan. Hij zit al 34 jaar in de keukens, begon 25 jaar geleden in een gehuurd pand zijn eigen bedrijf en heeft zich sindsdien ontwikkeld tot een professionele keukenleverancier.
“Dat komt vooral omdat veel klanten tegenwoordig het complete verhaal willen. We doen niet alleen de montage van de keukens op een bekwaam niveau, maar ook de plafonds en de vloeren, desnoods een complete renovatie. We maken dan een klein draaiboek voor de

klant. Die merkt duidelijk dat alles in één hand is en dat er ook maar één aanspreekpunt is tijdens de verbouwing. Dat wordt altijd als heel prettig ervaren,” vertelt Van der Meijde.
En: “Die laagdrempeligheid typeert ons: wij zijn betrokken en dichtbij. Wij nemen de tijd voor persoonlijke wensen en adviseren graag bij de aanschaf van een droomkeuken.
Onze monteurs zorgen vervolgens voor de vakkundige montage. Ook voor de renovatie van een bestaande keuken kan men heel goed bij ons terecht.”
Image Keukens heeft de afgelopen jaren naam gemaakt door mee te werken in grote projecten van bouwers als Vormbouw, de Langen & van den Berg, Waal, BM van Houwelingen, P & G Hooghwerff, van Agtmaal en Heijmans. Daarbij werd en wordt gewerkt door het hele land. Maar ook duidelijk in de Hoeksche Waard. Zo levert de keukenzaak uit Oud-Beijerland de komende tijd de keukens in De Waterborg in Puttershoek, waar op
de plek van het voormalige gemaal ‘t Hooft van Benthuizen 17 karakteristieke watervilla’s, gemaalvilla’s en appartementen verrijzen.
Ook wordt meegedaan aan het project Wonen Aan De Dijk aan de Oostdijk in Oud-Beijerland, waar komend jaar 12 woningen worden gerealiseerd op de plek waar 33 jaar een taxibedrijf zat. En voor de 23 appartementen in het appartementencomplex L’entrepôt, op de hoek van de Trambaan en de OudBonaventurasedijk in Strijen waar nu nog aardappelhandel G. Kruythoff & Zn is gevestigd, worden ook de keukens geleverd.
Het meewerken aan grote projecten door het hele land heeft er voor gezorgd dat Image Keukens meer klanten van buiten dan van binnen de Hoeksche Waard heeft. De mond-tot-mondreclame heeft er voor gezorgd dat ook veel particulieren de weg naar de showroom aan de Willem Beukelszstraat 4 weten te vinden.
Aan gestunt met apparatuur voor de halve prijs of gratis montage,
waarmee grote keukenketens aan de weg proberen te timmeren, doet het bedrijf van Van der Meijde niet.
Jeroen: “Ik ga de mensen niet voor de gek houden. Gratis montage? Dat geloof je toch zelf niet! Ieder weldenkend mens kan bedenken dat dit niet kan; dat moet ergens vandaan komen. Ik ga daar geen mensen mee lokken. Ik heb liever een klant die door een ander is geadviseerd om eens bij ons rond te kijken.”
Zwart en marmerlook
Zwart is de kleur die momenteel helemaal ‘in’ is bij klanten die een nieuwe keuken zoeken en een keukenblad in marmerlook. En of het nu om een kleine(re) of een grote keuken gaat, de klant gaat voor gemak en zo min mogelijk onderhoud: strakke, gladde keukens met greeploze laden (met vaak een lade in de lade) en deurtjes, vaak een apart blok waar alle apparatuur in zit en bij een grotere keuken bijna altijd een kookeiland. Van der Meijde: “Bovenkasten worden steeds vaker weggelaten. Immers: alleen lange mensen kunnen bovenin iets pakken of neerzetten. In de onderkas-
ten wil de klant veel laden. Die zijn lekker overzichtelijk.”
Elke keuken heeft een eigen sfeer, die bepaald wordt door tal van elementen, constateert Van der Meijde. Daarom heeft Image Keukens ook een uitgebreid assortiment wandtegels. En vloertegels natuurlijk die aan hoge eisen moeten voldoen omdat ze immers intensief belopen worden en het ontstaan van vlekken in een keuken ook niet uit te sluiten is. Ook wordt geadviseerd over zaken als de kleur van de voegen, de manier waarop de tegels worden gelegd en het creëren van een natuurlijke overgang met andere delen van de woning.
Van der Meijde: “Kom eens langs, u kunt rekenen op een warme ontvangst. Laat u inspireren door de wereld van Image Keukens.”

Image Keukens
Willem Beukelszstraat 4 3261 LV Oud-Beijerland t 0186-640244
e info@imagekeukens.nl i www.imagekeukens.nl
































Vooraf hoopten Bets en Bas Vogelaar op een halve ton als opbrengst van de 21e editie van de truckshow die ze op zaterdag 21 augustus hielden op het terrein van Novifarm aan de Middelsluissedijk in Numansdorp. Maar toen ze eind vorige maand in het Sophia-kinderziekenhuis in Rotterdam de cheque overhandigden, stond er toch maar mooi een bedrag van € 65.050,= op! Daarmee komt de totale bijdrage aan het kinderziekenhuis in ruim 20 jaar tijd op € 428.000,=.
Volgend jaar zou best eens het half miljoen kunnen worden be reikt, want een van de sponsoren heeft een auto, een Skoda Fabia (nieuwprijs € 22.000,=), beschikbaar gesteld die gaat dienen als hoofdprijs voor een grote verloting die in 2023 wordt gehouden. Bets en Bas zijn momen teel bezig om daarvoor
alle vergunningen binnen te krijgen. Er komen 5.000 loten op de markt die € 25,= gaan kosten. De trekking van die verloting is tijdens de truckshow in augustus 2023.
Tijdens een truckshow komen zo’n 125 trucks in alle soorten en maten vanuit de wijde omgeving naar Numansdorp. Vrachtwagenliefhebbers zijn er gewoon een paar
Bets en Bas Vogelaar overhandigen een cheque van maar liefst € 65.065,= aan het Sophia kinderziekenhuis.

dagen gezellig bij elkaar, er is een veiling en een verloting en er is van alles te eten en te drinken, alle opbrengsten gaan naar het goede doel. Om aandacht te vragen voor het evenement wapperen kleurige sponsorvlaggen (dit jaar zelfs 166) wekenlang langs de provinciale weg N487. Ook dat levert elke jaar weer veel geld op voor Sophia.
Het dit jaar bijeen gebrachte geld wordt onder meer gestoken in een snoezelbadkamer, een badkamer die is omgetoverd tot een magische omgeving waar kinderen heerlijk kunnen ontspannen tijdens de dagelijkse verzorging zoals het douchen of in bad gaan en waar ze even kunnen vergeten dat zij in een ziekenhuis zijn. Ook gaat er geld naar een PCCT-scanner, waarmee bij kinderen met een hartafwij king haarscherpe beelden kunnen worden gemaakt, en het project De Hartendief.
U zal er vast al over gehoord of gelezen hebben: de vernieuwing van het pensioenstelsel in Nederland. Hier wordt al jaren aan gewerkt en momenteel ligt het wetsvoorstel ter behandeling in de Tweede Kamer. Op dit moment is nog onduidelijk of deze wet doorgang zal vinden maar een aantal zaken is al wetgeving. Vanaf 1 juli 2023 wordt het o.a. mogelijk om maximaal 10% van het opgebouwde pensioenkapitaal ineens uit te laten keren bij pensionering (ook wel lump-sum genoemd door uw pensioenuitvoerder).
Opname bedrag ineens Het klinkt heel aantrekkelijk om als u met pensioen gaat, ineens te kunnen beschikken over 10% van het kapitaal in uw pensioenpot. Het bedrag mag namelijk vrij besteed worden waardoor bijvoorbeeld die prachtige reis na uw pensionering een stuk makkelijker te realiseren is. U kunt ook uw hypotheek of andere schulden aflossen of wilt u toch die mooie camper kopen? Er is wel een aantal aandachtspunten waar u rekening mee moet houden. Het bedrag wat u ineens opneemt, wordt direct belast met loonheffing. Dit kan belastingtechnisch gevolgen hebben als u op uw pensioendatum de AOW-gerechtigde leeftijd nog niet heeft bereikt. Pas vanaf deze leeftijd is de belastingdruk in de 1e schijf lager en betaalt u minder heffing over het bedrag. Het moment van opname van het bedrag kan dus verschil maken.
Regels om rekening mee te
Als u gebruik maakt van de lumpsum, vervalt de optie om bij uw pensioenuitkering te kiezen voor de hoog/laag regeling (pensioen dat eerst hoger is en daarna lager).
Ook de partner moet instemmen met de afkoop als het bedrag van het nabestaandenpensioen hierdoor lager wordt.
Er kunnen ook fiscale gevolgen zijn als u in de lagere of middeninkomens valt. Het bedrag ineens wordt bij uw inkomen opgeteld waardoor er een kans is dat uw recht op toeslagen lager wordt.
Realiseer u goed dat na opname van dit bedrag er minder geld in uw pensioenpot zit waardoor de pensioenuitkering die u gaat ontvangen lager wordt. De pensioenuitkering die resteert na afkoop moet minimaal een bedrag van € 520,35 per jaar (2022) bedragen. Is het bedrag wat overblijft, voldoende voor uw uitgaven en vaste lasten in de toekomst? Of moet u dan op een houtje bijten?
Kortom: er is meer keuze als u met pensioen gaat maar tegelijk wordt het moeilijker om een zorgvuldig besluit te nemen. Laat u goed informeren wat uw mogelijkheden zijn en wat de financiële gevolgen in uw persoonlijke situatie zijn. Wij helpen u graag bij het maken van de juiste keuzes. Neem hiervoor gerust contact met ons op via 0186-820000 of mail naar: annemiek@overwater-pensioen.nl. www.overwater-advies.nl
Op dinsdag 8 november reikte burgemeester Aptroot in het gemeentehuis van Maasdam de Oranjewimpel uit aan de Oranjevereniging ’s-Gravendeel. De Oranjewimpel is een konink lijke onderscheiding die wordt toegekend aan Oranjeverenigin gen die 50 jaar of langer bestaan, als blijk van waardering voor hun inzet. Oranjevereniging ’s-Gravendeel viert dit jaar haar 100-jarig jubileum. Burge meester Aptroot feliciteerde de vereniging namens het gemeen tebestuur van harte met deze mijlpaal en met de koninklijke onderscheiding.
Oranjevereniging ’s-Gravendeel is de eerste Oranjevereniging in gemeente Hoeksche Waard die de Oranjewimpel heeft ontvangen. De vereniging kijkt terug op een rijke geschiedenis. Burgemeester Aptroot sprak zijn trots uit: “Vanaf dat eerste moment in 1922 is de Oranjevereniging een verbindende factor geweest in het dorp. Nu, 100 jaar later doet Oranjevereniging ‘sGravendeel nog altijd alles samen, met de andere verenigingen, on dernemers en inwoners. Juist daar zit de kracht om het zo lang vol te houden: lokale verbondenheid.”

Enthousiaste vrijwilligers, professioneel en eigentijds Ook waren er grote complimen ten voor de inzet van de vele
enthousiaste vrijwilligers en de professionele manier waarop de Oranjevereniging al een eeuw lang festiviteiten voor jong en oud organiseert. Oranjevereniging ’sGravendeel is met haar tijd meege gaan en staat nog altijd midden in de samenleving. Zelfs toen door de coronabeperkingen Koningsdag en de 4-meiherdenking op een andere manier moesten worden ingevuld, liet de vereniging zien zeer vinding rijk te zijn.
Speciaal voor het jubileumjaar is een uniek fotoboek uitgegeven, vol met prachtige plaatjes van leden van de Oranjevereniging, fami liekiekjes van inwoners en foto’s van offici le fotografen. ‘100 jaar
Oranjevereniging ’s-Gravendeel’ roept herinneringen op aan vervlogen tijden. In het boek is bijvoorbeeld een oud program maboekje van de eerste viering van Koninginnedag na de Tweede Wereldoorlog opgenomen. Meer in formatie is te vinden op de website www.oranjevereniging sgravendeel.nl
Koninklijke onderscheiding Ter gelegenheid van het gouden huwe lijksjubileum van Prinses Juliana en Prins Bernhard in 1987 heeft Koningin Beatrix besloten een Oranjewimpel toe te kennen aan Oranjeverenigingen die minimaal 50 jaar bestaan (en daarna oplo pend met 25 jaar).
5 jaar geleden opende bio logische boerderijwinkel Doelwyck haar deuren. En dat vieren ze met koffie/thee en wat lekkers voor hun klanten op vrijdag 18 en zaterdag 19 november. Voor de winter maanden wijzigen vanaf 18 november de openingstijden. Op vrijdagmiddag sluit de winkel een uurtje eerder, om 17.00u. en op zaterdag is de winkel tot 13.00u geopend.
Matthijs en Shaula Tak willen smaakvolle biologische groenten & fruit makkelijker beschikbaar maken en hun bijzondere boer derij openstellen voor publiek. De groenten en fruit komen van eigen boerderij, van bio-boeren uit de regio en van verder weg om voldoende variatie aan te kunnen bieden. Ze vertellen je graag over de herkomst, de bijzonderheden van de teelt, gebruik en berei dingstips. Klanten komen uit de Hoeksche Waard, maar ook van Voorne Putten, Goeree Overflak kee en zelfs vanuit Rotterdam en Drechtsteden stappen mensen in
hun auto voor de verse biologische groenten, fruit, kaas en vlees. De eerste 2,5 jaar was de winkel in een knusse verkoopruimte met een antieke grutterskast en een vloer van ijsselsteentjes. Van wege Corona verhuisden ze de winkel naar de inrit van de grote rietgedekte schuur, waar een veel ruimere opstelling mogelijk is. Aan ruimte geen gebrek zul je denken. Maar hier worden doordeweeks de Bioaanhuis foodboxen samen gesteld en vullen bezorgers hun bestelbussen om deze pakketten vervolgens bij de abonnees in heel Zuid-Holland te bezorgen. Nadat vrijdagmorgen de laatste chauf feur vertrokken is wordt de schuur geveegd en de Pop-up winkel voor bereid en vanaf 14.00u kunnen klanten twee dagen heerlijk verse groente & fruit shoppen. Inmiddels hebben heel wat mensen hun weg naar de boerderijwinkel weten te vinden. Ook is er kaas van Biostee en biologisch rund, lams- en var kensvlees verkrijgbaar.
Voor adres & openingstijden: www.doelwyck.nl
“Boerderijwinkel

Zingende kinderen, ondeugende pieten en een zwaaiende goedheiligman. We kunnen er niet meer omheen. Sinterklaas houdt ons de komende tijd in een gezellige greep. et Sinterklaasfeest blijft onverminderd populair.
HHet aantal Nederlan ders dat pakjesavond viert, neemt gestaag toe. Vriendengroepen, families en verenigingen plannen avondjes waarop gedichten, ca
deautjes en typische Sinterklaas lekkernijen de hoofdrol spelen.
De geschiedenis van het Sinter klaasfeest vertelt verschillende verhalen. Volgens een oude le gende was Sinterklaas vroeger bis
schop van het Turkse plaatsje Myra. Daar was hij erg geliefd omdat hij geld en eten gaf aan arme mensen en kinderen. Daar zou ook de be naming ‘goed heiligman’ vandaan komen, zo luidt een van de vele verklaringen. Wel zeker is dat Sinterklaas tegen woordig in Spanje woont. Daar wordt zijn bezoek aan Nederland al maanden van tevoren voorbe reid. Er worden pakjes ingepakt,
pepernoten gebakken en brieven van kinderen nagelezen. Enkele weken voor de intocht - die altijd half november plaatsvindt - stap pen de Sint en zijn pieten vervol gens op Pakjesboot 12 om koers te zetten naar Nederland.
Het Sinterklaasfeest blijft onverminderd populair. Foto: Wim Kluvers.
Ook dit jaar is Sinterklaas niet van de beeldbuis af te slaan. De camera’s van diverse televisieom roepen zijn op de goedheiligman en zijn pieten gericht. En ook dit jaar heeft Sinterklaas zijn eigen journaal.
Het best bekeken kin derprogramma van de NTR, Het Sinterklaas journaal, is niet meer weg te den ken van de beeldbuis. Jaar na jaar doet het journaal verslag van de


Als er één feest is waar er door iedereen gesnoept mag worden, dan is het wel het Sinterklaasfeest. Dat begint al met het strooien van pepernoten door zwarte piet. Maar verder liggen de winkels ook vol met speculaaspoppen, chocoladeletters, gevuld speculaas, banketletters en marsepein.

We kennen allemaal het tafereel. Plotseling wordt er hard op de deur geklopt, een hand verschijnt en de pepernoten vliegen door de huiskamer. De traditie van het strooien hoort bij het sinterklaas feest. Net als al die lekkernijen. Al leen daarom is het sinterklaasfeest al de moeite waard.
De chocoladeletter doet het als vanouds goed. Lekker om te krij gen, maar ook leuk om weg te
geven. Je hebt basisletters van al leen chocolade, maar ook goed gevulde exemplaren. En twijfel je over de letter. Dan kies je gewoon voor de S van sint!

Het strooigoed bestaat vooral uit pepernoten, tumtummetjes en schuimpjes. Soms zitten er in het strooigoed ook taaitaai poppetjes en suikergoed. Smullen! En voor de buitenintochten zorgt Sinterklaas voor snoepgoed met een papiertje er omheen.
Een typisch sinterklaasgerecht is marsepein, een deegachtig meng sel van gemalen amandelen en suiker. Je moet het eigenlijk bij de banketbakker kopen om de echte smaak te proeven. Marsepein wordt vaak gebruikt om taart te decoreren, maar in de weken voor Sinterklaas worden er poppetjes van gemaakt.
Smullen van pepernoten en gevuld speculaas.
ontwikkelingen rondom het ver blijf van Sinterklaas en zijn pieten in Nederland. En net zoals elk jaar blijft het de vraag of alles dit keer zonder problemen verloopt. Pre sentatrice Dieuwertje Blok houdt ons elke dag op de hoogte van de ontwikkelingen en achtergronden rondom de intocht, het verblijf en de verjaardag van Sinterklaas. En gebeurt altijd wel iets geks. Zo werden de pieten vorig jaar ge volgd op de stoomboot en beleef den ze daar spannende avonturen. Dat zal dit jaar niet anders zijn. En dankzij het Sinterklaasjournaal kunnen wij het allemaal volgen. Daarnaast zal de goedheiligman
in de dagen voor en tijdens zijn verjaardag ook op andere zenders te zien zijn. De ene keer speelt hij in een spannende film, de andere keer is hij te gast in een televisie show. Vooral rond pakjesavond.

Sinterklaas zegt tegen een zwarte piet: “Je pakt langzaam in. Je schrijft gedichten langzaam, je loopt langzaam over daken. Is er niets dat je vlug kunt?” Zwarte piet: “Jawel hoor. Ik ben vlug moe.”


















Het is deze maand alweer tien jaar geleden dat Miriam Martens en haar dochter Merel Dresswaar & Zo openden aan de Voorstraat 53 in Numansdorp. Samen startten ze een winkel met nieuwe woonaccessoires, veel vintage meubelen en 8 soorten losse thee.


Al na enige tijd kwa men ze erachter dat de vraag naar vintage meubelen afnam, omdat erin de Hoek sche Waard steeds meer kring loopwinkels hun deuren openden. Tegelijkertijd groeide de vraag naar losse theesoorten. Ze besloten het roer om te gooien en zich meer

te gaan richten op de thee en alle bijbehorende producten. En met de verhuizing in 2016 naar het 50 meter verderop gelegen pand aan de Burgemeester De Zeeuwstraat 3 B werd de naam omgedoopt tot Dresswaar & Thee.
“Een keuze waar we nog steeds heel blij mee zijn”, vertelt Miriam. “In middels verkopen we meer dan 200 soorten losse thee, onderverdeeld in zwarte, groene, witte thee en natuurlijk rooibos en kruiden- en fruitmelanges. Onze klanten kun nen al vanaf 50 gram per soort bij ons kopen, zodat ze ook thuis kun nen genieten van een ruime keuze. Naast thee verkopen we ook allerlei producten die bij thee horen, zoals warm houdbare theepotten, glazen
Eigenaar Jeroen de Jong deelt het pand met Gotcha, de kapsalon van zijn partner Astrid. “Gotcha bestaat al heel wat jaartjes en wilde verhuizen naar een groter pand. Dit pand van de voormalige fietsenzaak kwam beschikbaar en bood ons de kans om naast de kapsalon nog een andere zaak op te zetten.
theepotten met filter, theeglazen, theedozen, theezeefjes, te veel om op te noemen… Voor de koffielief hebber hebben we verschillende soorten koffiebonen uit Ecuador, vers gebrand in Numansdorp in ons assortiment ”
En bij een lekkere kop thee hoort natuurlijk goede chocolade. Dresswaar verkoopt rond de zestig soorten handgemaakte bonbons. Het assortiment bevat klassiekers, maar wordt al naar gelang het seizoen aangevuld met herfst-, Sint- of Kerstbonbons. De bonbons worden ter plekke voor de klant in een doosje gedaan, dus je kan zelf een keuze maken uit de bonbonvi trine. Daarnaast verkopen ze ook veel andere chocoladeproducten. Bijvoorbeeld pindarotsen van Callebaut chocolade, de echte cho coladeBikkels en chocoladekogels met Baileys of whiskeysmaak.
Natuurlijk zijn thee en bonbons erg leuk om weg te geven óf om te krijgen, maar Dresswaar & Thee verkoopt nog veel meer originele cadeaus. Keukentextiel van Clayre en Eef zoals theedoeken, oven wanten, keukenschorten in de meest mooie dessins; fotolijstjes in diverse formaten, mooie bekers en thermoflessen van William Morres en ook het prachtige Delftsblauwe servies ontworpen door Heel -Holland-Bakt-coryfee Janny van der Heijden.
November is het feest bij Dresswaar & Thee met diverse aantrekkelijke aanbiedingen. Die worden via de socials bekend gemaakt, dus houd Facebook en
Instagram in de gaten! Dit alles op hun eigen gezellige manier, die door de klanten zo gewaardeerd wordt. Want hoewel ze inmiddels de groot ste theewinkel van de Hoeksche Waard en omgeving zijn, heerst er altijd een huiskamergevoel bij Miriam en Merel waar iedereen van harte welkom is om iets te kopen of te genieten van een kopje thee of koffie met huisgemaakte taart in de winkel of bij goed weer op het terras.
December Voor de Decembermaand is Dresswaar & Thee bij uitstek het juiste adres. Sint heeft hier voldoende keuze en kan ook tegelijk bijzondere chocoladeletters inslaan. Met de hand opgespoten chocoladeletters in bijvoorbeeld whiskey-, koffietiramisu- of bitter koekjessmaak of een met praliné gevuld exemplaar. Wie zou dat niet in zijn of haar schoen willen… Voor de Kerstdagen verkopen Merel en
Ben je op zoek naar een smake lijk cadeau of wil jouw bedrijf de klantenkring verrassen met een origineel relatiegeschenk, vraag Miriam en Merel dan naar de mogelijkheden. Zij maken de leukste pakketten om te geven met mooie artikelen om te bewaren en de lekkerste producten om van te smullen.
Dresswaar & Thee Burg. De Zeeuwstraat 3 B Numansdorp t 0186 651 560 e info@dresswaar.nl i www.dresswaar.nl

Openingstijden: Dinsdag t/m donderdag: 10.00-17.30 uur Vrijdag: 10.00-20.00 uur Zaterdag: 10.00-17.00 uur
We hebben toen goed gekeken waaraan er behoefte is in Zuid-Beijerland en de omliggende dorpen. Op het gebied van kinderkleding is er weinig aanbod en zodoende hebben we de keuze gemaakt voor een kinderkledingzaak. “
De formule van een gecombineerd pand met zowel een kapper als kinderkleding onder één dak is uniek. “Terwijl je kind geknipt wordt kun je zelf even tussen de kinderkleding kijken. En terwijl jij je haren laat verzorgen, kan je kind spelen in onze speelhoek. Dat zorgt voor een ongedwongen sfeer. Even snuffelen naar iets leuks voor de kinderen? Je bent van harte welkom en ook de kinderen mogen hier zichzelf zijn. Ongemerkt kan
je ze die nieuwe broek en trui laten passen, terwijl zij ondertussen aan het spelen zijn. We hebben mooie kinderkleding van maat 50 tot en met 176. Dus voor de allerkleinsten tot aan pubers. We voeren merken zoals Daily Seven, Dirkje, Babyface, Cars, Retour Jeans, Koko Noko, Geisha, Frankie & Liberty en Rellix en hebben de winkel zoveel moge lijk op thema en leeftijd ingericht. Dat maakt het makkelijk om de allerleuke combinaties te vinden voor zowel jongens als meisjes.”, vervolgt Jeroen trots.
Naast kinderkleding vind je bij Heb bes! ook grappige en mooie kado’s in de speciale kadohoek voorin de winkel. Dus ben je op zoek naar een origineel kraamkado, een duurzaam verjaardagskado of iets leuks voor in de schoen binnenkort, stap dan ook gerust binnen bij Hebbes! De kans dat je er slaagt is enorm groot.
Bovendien kan je nog de hele maand november profiteren van de kortingsactie bij Hebbes! Bij aankoop vanaf 35 euro, ontvang je op de gehele collectie kinderkleding 10 procent kassakorting. Is dat even mooi meegenomen in deze dure tijd!
Hebbes! Kinderkleding is geopend van dinsdag tot en met zaterdag van 9.00 tot 17.30 uur. Een webshop hebben ze niet, want ze vinden het veel te leuk als je zelf langs komt in de winkel en op je gemak door de collectie struint op zoek naar iets waarvan je denkt: Hebbes, die is voor mij!
Hebbes! Kinderkleding Gravin Sabinastraat 38B
Zuid-Beijerland t 06-23469573 i
Dresswaar & Thee is met meer dan 200 soorten thee de grootste theespecialistMiriam allerhande lekkere delica tessen en natuurlijk speciale kersten winterthee.
































Iedereen is nét even anders. Dus een matras dat goed bij je past, is ook persoonlijk. Dat weten ze bij Slaapboulevard Kwakernaat, aan de Boonsweg 7 in Heinenoord, maar al te goed. Daarom hield in het eerste weekend van deze maand, tijdens een Fysio Event, erkend fysiotherapeut Kay Woudstra er een paar keer een lezing waarin hij alles vertelde over anatomie, lichaamsvormen, slaaphoudingen en slaapfases. Ook konden de bezoekers er proefliggen.
et juiste ma tras nodigt het lichaam uit om een goede slaaphouding aan te nemen en roept geen weerstand op vanuit het lichaam,” vertelde Woudstra zijn aandachtige gehoor. Woudstra is gespecialiseerd in de uit zeven nek wervels, twaalf borstwervels, vijf
“Hlendewervels en vijf staartwervels bestaande wervelkolom, die bij het slapen zoveel mogelijk recht moet liggen en zo min mogelijk gebogen moet zijn.
Maar er zijn nu eenmaal veel verschillende bodytypes: brede en smallere heupen, brede schouders en smallere schouders en dat ligt allemaal anders op een matras.
“Een bed bestel je dan ook niet op internet. Dat kan écht niet! Proef liggen móet,” hield Woudstra zijn gehoor voor. “Want pas als je op een bed hebt gelegen, weet je of het aan je slaapwensen voldoet. Je moet proefondervindelijk ontdekken wat je nodig hebt voor een goede nacht rust. Gezond slapen is belangrijk. Je brengt tenslotte een derde van je leven in bed door. Een bed, en vooral dus het matras, moet passen bij het postuur van het lichaam.”
Daarom konden de bezoekers na afloop ook proefliggen en direct de zojuist opgedane kennis toetsen op een van de 130 bedden, met maar
liefst 200 verschillende matrassen, in de showroom van de bedden speciaalzaak in Heinenoord. Toen bleek ook dat in een 2-persoons bed vaak twee verschillende matrassen moeten. Man en vrouw verschillen nu eenmaal qua postuur. Ook een passend kussen is daarbij belang rijk. “Een verkeerde matras kan er niet alleen voor zorgen dat iemand



vermoeid opstaat, maar ook kun nen lichamelijke ongemakken zoals rug- en nekklachten optreden. Ook uit preventief oogpunt is het van belang dat de ideale slaapcom binatie wordt samengesteld. Dit gebeurt aan de hand van lichaams bouw, gewicht en slaapgewoonten,” aldus Kay Woudstra.
In de 4000 m² showroom, met het grootste assortiment bedden en bedtextiel in de regio Rotterdam, is alles op het gebied van comfortabel en gezond slapen te vinden en is altijd een oplossing te vinden die bij een klant past. Kay (’Wist je bijvoor beeld dat je elke dag twee tot drie centimeter ‘krimpt’ en dit ‘s nachts weer wordt hersteld?’) en de slaap adviseurs van Kwakernaat gaven daarbij ergonomisch advies om zo samen het ideale matras te vinden. Dat lukt in Heinenoord altijd, want Slaapboulevard Kwakernaat (’Jouw nachtrust, onze zorg’) is dealer van topmerken als Auping, Tempur, Pullman en Hästens.
Landelijke wonen aan de rand van Strijen Land van Essche ligt heel landelijk, aan de rand van Strijen. Als je er graag op uittrekt, zit je hier goed. Wandelen, fietsen, mountainbiken en golfen, het kan hier allemaal in de buurt. Het leuke aan Land van Essche is dat het landelijke, dorpse karakter van de omgeving zijn weg straks ook vindt in de nieuwbouwwijk.

Het aanbod van woningen is heel divers


starterswoningen
rijwoningen in diverse breedtes
twee-onder-een-kapwoningen
vrijstaande huizen
appartementen/penthouses
levensloopbestendige woningen Prognose start verkoop 2e kwartaal van 2023













































Jan en Karin Verhoeven runnen al bijna 30 jaar een kaasspeciaalzaak in het centrum van Numansdorp. Met meer dan 200 soorten kaas uit binnen- en buitenland biedt de Kaashoeve haar klantenkring een prachtig assortiment. Maar in plaats van door te borduren op het huidige succes, zaten zij al enige tijd na te denken over een nieuw idee. Nu, na twee jaar van voorbereiding, is het dan zover en brengt De Kaashoeve een eigen serie private label producten uit onder de naam ‘De Hoeksche Gebroeders”.


Op zaterdag 26 november a.s. vindt de eerste editie plaats van “Dorffest im Koningshoeve”. Een nieuwe opzet van het ‘kapellenfestival’ van de Egerländerkapel van muziekvereniging Prinses Juliana uit Klaaswaal. Bezoekers kunnen zich opmaken voor een gezellige, muzikale avond met Blasmusik van de bovenste plank!
Egerländerkapel Die Alpenjäger uit Klaaswaal zoals de kapel voluit heet, bestaat uit 20 muzikanten. De kapel
Trots vertelt Jan Verhoe
ven dat hij merkte dat er in de markt behoefte is aan ‘eigen’ Hoeksche Waardse producten. “Wij krijgen vaak de vraag in onze winkel of er producten zijn uit de Hoeksche Waard, die als pakket samengesteld kunnen worden. In onze gemeente waren er nog weinig dergelijke producten. Dus zijn wij ons gaan oriënteren op de diverse mogelijkheden. Voorop staat dat het producten van goede kwaliteit moesten zijn en dat ze moeten passen bij onze kaasspeciaalzaak. En zo ontstond langzamerhand een lijn aan producten die stuk voor stuk heel lekker zijn en die samen leuk te combineren zijn.”
De volgende stap was het bedenken van een aansprekende naam en een pakkend logo. Voor de naam of nu officieel het merk genoemd werd de inspiratie thuis gevonden. Zoals veel klanten weten werkten er door de jaren heen vaak meer dere gezinsleden in de winkel. Mo menteel werkt zoon Jan dagelijks in De Kaashoeve en is zoon Mark voor de zaak op de achtergrond actief. Twee zonen, twee broers: De Hoeksche Gebroeders waren ‘geboren’. Voor het logo is een oude foto van de twee broers gebruikt. Samen met de naam De Hoeksche Gebroeders en het wapen van de gemeente Hoeksche Waard een aantrekkelijke combinatie.
Welke producten van De Hoeksche Gebroeders mag u verwachten? Momenteel bestaat het assortiment uit drie soorten kaas (Hoeksch Hoekje Belegen, Hoeksch Hoekje Oud en Hoeksch Hoekje Kruiden),
Port, rode en witte wijn, advo caat, olijfolie, balsamico, mosterd dille saus, diverse soorten noten, kaaszoutjes en heerlijke bonbons. Allemaal met een originele naam zoals Kaasjuweeltjes, Hoeksche Knabbels, Hoeksch Kaatje en Hoeksch Genot. Hiervan maken ze bij De Kaashoeve prachtige pakketten in diverse prijsklassen. Eventueel gecombineerd met een kaasplank met uw eigen logo of dat van ‘De Hoeksche Gebrouders’ erin gebrand.
Inmiddels hebben ‘De Hoeksche Gebroeders’ Jan en Mark op vrijdag 4 en zaterdag 5 november jl. de nieuwe producten geïntroduceerd in de winkel en de reacties waren overweldigend. Was u niet in de ge legenheid om kennis te maken met De Hoeksche Gebroeders, kom ze dan bekijken in de winkel. Ze vertel len u graag over de mogelijkheden.

De Kaashoeve
Voorstraat 18, Numansdorp i www.dekaashoeve.nl i www.dehoekschegebroeders.nl
onder leiding van Alex Rommers speelt volksmuziek uit Bohemen (Tsjechië) in de stijl zoals die ooit door Ernst Mosch is ontwikkeld.
Dat is Egerländermuziek, genoemd naar de streek in Bohemen waar deze muziek voornamelijk zijn oorsprong heeft. Deze blaasmuziek
is vrolijk van karakter en is daarom uitermate geschikt om een feestje mee te vieren.

Dat gaat gebeuren op 26 november a.s. in de nieuwe feestzaal van Restaurant De Koningshoeve aan de Botweg in Klaaswaal. Onder de naam ‘‘Dorffest im Koningshoeve’’ wordt een muzikale avond met Blasmusik van hoog niveau georganiseerd. In tegenstelling tot de bekende Oktoberfesten is het Dorffest een echt muziekfeest en geen bierfeest. Alle leeftijden zijn dan ook van harte welkom!
Voor deze eerste editie van het Dorffest heeft Die Alpenjäger, blaaskapel De Essener Muzikanten uit het Belgische Essen weten te strikken. Zij zijn meermalig Belgisch kampioen in de Topklasse. In traditionele bezetting brengen deze muzikanten een gevarieerd programma met

vurige polka´s, meeslepende walsen en spectaculaire solowerken ten gehore. Natuurlijk zal Die Alpenjäger ook van zich laten horen tijdens dit Dorffest. Je wordt door de muzikanten meegenomen op een muzikale reis met originele Egerländer en Böhmischemuziek. De klassiekers afgewisseld met nieuwe muziek en solostukken staan garant voor een leuk, afwisselend muzikaal programma. Tijdens de optredens door wordt je vermaakt door niemand minder dan DJ Alex en kunnen ook de voetjes van de vloer.
Wie dus houdt van een gezellige avond met goede Blasmusik, doet er goed aan snel een kaartje te kopen voor deze eerste editie van het “Dorffest im Koningshoeve” op 26 november a.s. De zaal gaat open om 19.00 uur en de entree is € 7,50 incl. drankje. Reserveren van kaarten doe je via info@diealpenjager.nl

De sprong wagen en een overstap maken? Misschien is dit wel jouw moment!





Halte Zomervilla is gestart door ouders en gevestigd in een prachtig verbouwde kerk waar letterlijk en figuurlijk ruimte is voor jouw ideeën. Liefde, ontwikkeling, sfeer, aandacht, welzijn, respect en verbondenheid zijn onze belangrijkste pijlers. We hebben voldoende tijd en aandacht om maximaal vijftien EMB-jongeren die bij ons wonen en logeren een hoge kwaliteit van zorg te bieden.
Ons team is op zoek naar diverse begeleiders gehandicaptenzorg. Op onze web site vind je meer informatie.
Wil jij de stap maken? We maken graag kennis met je!





Banketbakster Kaylee van Bakkerij Boender heeft 9 november op het onderdeel Roomboter Amandelletter de derde prijs gehaald tijdens de Nederlandse kampioenschappen BakkersVakWedstrijden in Heerenveen.
De Nederlandse kampioenschap pen BakkersVakWedstrijden is het hoogst haalbare wedstrijd niveau in Nederland. De beste bakkers van Nederland strijden tijdens de BakkersVakWedstrijden om de hoogste eer. In totaal zijn er meer dan 600 producten verdeeld over 24 klassen inge zonden. Meerdere professionele juryleden beoordeelden per klasse de producten op 10 voor die klasse specifieke criteria. In de klasse Roomboter amandelletter was dit jaar de op dracht om een letter B in te leveren. De letter B is niet per toeval gekozen. Anders dan een letter M of S is de letter B een stuk lastiger te maken. De letter moet namelijk op twee plaat sen met elkaar verbonden worden.
De door Kaylee van Bakkerij Boender ge maakte roomboter amandelletter scoorde ten opzichte van de andere deelnemers het hoogste op de criteria kleur en smaak van het korstdeeg. Een bijzonder lekkere roomboter amandel letter dus! Voor een nog betere let ter dan die van Kaylee moet je trouwens een eindje omrijden. Bakkerij Dunselman uit



Creëer een magische sfeer met onze 1.950 speciale kleuren. Maak kleurcomposities om verliefd op te worden!
Onze lievelingskleuren onthullen wie we zijn. Kleuren geven sfeer en beïnvloeden onze stemming. En de juiste sfeer en stemming inspireren, motiveren, kalmeren en inspireren ons.



Dus waarom zou u uw eigen keuken niet inrichten met uw eigen favoriete kleuren? Het is per slot van rekening de ruimte waarin we veel tijd doorbrengen. We koken er voor en met ons gezin, familie en vrienden, genieten er met elkaar, voeren er ontelbare gesprekken en beginnen er de dag en vaak eindigen we hem er ook nog, met een gezellig drankje.
SieMatic brengt daarom nu kleur in uw keuken Maak kennis met extraverte keukens met felle en kleurrijke ontwerpen of laat u inspireren door subtiele, monochrome keukenconcepten. Bij SieMatic ziet u in elk opzicht een breed scala aan design, kleur en stijl. Het verbindende element is de kwaliteit van een tijdloos elegant merk.
Wij vertellen u er graag meer over in onze showroom. Welkom!

Joost Kievit (75) is sinds 2019 bestuursvoorzitter van Water Natuurlijk, de partij die zich binnen het waterschap Hollandse Delta inzet voor een groenere benadering van de watergangen, bermen en dijken. Voordien was de oud-politieman 21 jaar voorzitter van Hoekschewaards Landschap, de natuurbeschermingsorganisatie die in 2023 vijftig jaar bestaat. Joost Kievit woont in het landelijk gebied van ’s-Gravendeel. Hun vrijwel energieneutrale huis is omgeven door oude fruitbomen, een wei voor paarden en kippen en ze eten van de gewassen uit de uitgestrekte groentetuin. Joost is getrouwd met An; ze hebben twee dochters en vier kleinkinderen.


“Waterschappen zijn in ons land de grootste groenbeheerder buiten de natuurgebieden. Het waterschap Hollandse Delta, dat zich uitstrekt over de Hoeksche Waard en vier andere Zuidhollandse eilanden, beheert 3200 kilometer wegbermen, 12000 kilometer oevers en 800 kilometer dijken. Wij vinden dat het waterschap groener en socialer moet worden. Groener door meer te doen aan het ontwikkelen van biodiversiteit. Dat is ieders maatschappelijke plicht, dus ook die van het waterschap. Natuurlijk, het waterschap zorgt voor droge voeten, dat er geen overstromingen komen. Maar er moet op het gebied van het groen rondom het water veel meer gebeuren. Want het gaat slecht met de biodiversiteit in ons land. Wij willen dat er een beter beheer komt, dat er meer soorten planten, bloemen, kruiden en struiken worden aangeplant. Want die zijn belangrijk voor de insecten, die op hun beurt weer belangrijk zijn voor vogels en zoogdieren.
Dat langs de dijken beter geen bomen wortelen, is echt een heel oude, conservatieve gedachte. Bovendien is het onzin, want al die planten en struiken zorgen voor een heel netwerk van wortels waardoor de dijk juist sterker wordt. We zetten ons ook in voor het behoud van bomenrijen op de dijken. Dat is hard nodig, want een boom die omwaait, wordt weggezaagd en niet vervangen.

Langs de Spuidijk tussen NieuwBeijerland en Piershil staan er nog maar 34 van de oorspronkelijke 180 bomen. Waarom? Er is geen reden. Maar dan komen ze met het argument dat zo’n boom gevaarlijk is. En als hij omwaait dat dan de wortels de grond mee trekken en dat er dan schade aan de dijk is. Meer bomen zijn juist enorm belangrijk, voor de biodiversiteit en voor het klimaat. Ze nemen met al hun bladeren veel CO2 op en leggen dat in hun takken vast voor langere tijd.
Sommige mensen bij de waterschappen vinden bomen gewoon
lastig. Maar wij vinden dat meer bomen een belangrijk maatschappelijk doel ondersteunen. Breid het bomenbestand juist uit! Daar is nota bene een nationaal beleid voor. Dus het waterschap moet daar ook in mee, vinden wij. Wij krijgen ook veel tips van bezorgde Hoekschewaarders die zien als er iets onheus gebeurt met de natuur. Onlangs werden we getipt over het kappen van 3 hectare houtopstand aan de Schuringse Havenkade bij Numansdorp. Op particulier terrein, dus geen bomen van het waterschap. Toen hebben we toch maar een bericht uitgestuurd. De raadsleden van de gemeente Hoeksche Waard moeten dat oppakken.
Een paar jaar geleden wilden ze op Goeree Overflakkee 1100 populieren kappen. Dat leidde tot grote verontwaardiging en er volgde een actie van een groot, betrokken publiek. Er kwam een petitie, die duizenden keren werd ondertekend, er kwam een enquête, er volgde een advies aan het waterschap en dat ging uiteindelijk aan àlle gemeenten in de Hollandse Delta.
De belangrijkste boodschap was: richt je niet zozeer op individuele bomen, maar kijk naar het grote geheel. Je moet een vervangingsbeleid hebben. Eén boom is een ecosysteem op zich, maar een hele rij is nog veel waardevoller. Het is een route voor insecten en vleermuizen. Bovendien is zo’n bomenrij beeldbepalend in het landschap. Als zo’n hele rij in een keer wordt gekapt, slaat dat in als een bom.
We krijgen ook veel meldingen over het kappen en snoeien in het broedseizoen. Het waterschap heeft daar nooit zoveel oog voor gehad. Zo’n klus wordt uitbesteed aan een aannemer. Ik ga er dan heen en dan staat zo’n jongen al met een kettingzaag in een hoogwerker. Die zegt dat íe dan eerst kijkt of er een nest zit. Maar hij vergeet dat die hoge takken naar beneden storten die dan onzichtbare nesten meesleuren. We hebben een Meldpunt Maaimisstanden opgericht. Daar zijn in de voorzomer maar liefst 2300 meldingen op binnengekomen. Die hebben we gebundeld en gepubliceerd.
Inmiddels wordt zestig procent van de bermen al ecologisch beheerd. We zijn echt wel op de goede weg. Gelukkig zijn er ook bij het waterschap steeds meer mensen met een groen hart. Dat is niet alleen fijn voor de natuur, maar ook voor het imago van het waterschap.

Behalve voor de natuur op de dijken en in de bermen, zetten we ons in voor het waterleven. Dieren onder water moeten zich kunnen verplaatsen. Er zijn zo’n 2000 plekken waar vissen niet doorheen kunnen, zoals stuwen en sluizen. Ook de waterkwaliteit is slecht. Die van de grote rivieren is enorm vooruitgegaan, maar met de kleinere waterwegen doen we het als Nederland het slechtst in Europa. Dat komt vooral door de meststoffen en bestrijdingsmiddelen van de landbouw. We streven naar meer natuurlijkvriendelijke oevers met meer planten, want die zuiveren het water. Maar ja, dat kost ruimte en dus geld. In een paar gevallen is het in de Hoeksche Waard al goed gelukt met overhoekjes van de kreken. Dat zijn schitterende gebieden geworden.
Behalve groener willen we ook graag dat de waterschappen socialer worden. Het waterschap heft belastingen. Daarin is een onevenwichtigheid; de bedrijven en de landbouw betalen naar verhouding te weinig en de burgers teveel. Wij willen clementie voor de mensen die het minder goed hebben; daar moet ook kwijtschelding voor mogelijk zijn.
Ik ben ook nog voorzitter van ‘Hoeksche Waard zoemt’. Dat is een collectief van organisaties en mensen die aan biodiversiteit werken. We hebben met ons project ‘Wegen voor de natuur’, waarin we natuurgebieden met elkaar verbinden om migratie van dieren te bevorderen, 25 mille subsidie gekregen. Met het geld schaffen we onder meer bomen en struiken aan. En we beginnen met een ‘bomenhub’ waar we bomen die over zijn en zaailingen gratis geven aan mensen die ze willen planten. Dat alles om







Vitaal zijn is iets wat we allemaal graag willen: zonder belemmeringen functioneren en zorgeloos kunnen bewegen. Helaas is het vaak anders en zit menigeen met een pijnlijke voet, een zere knie of irritatie in de heupen. Of misschien bent u wel één van de vele mensen met rugpijn. Maar hoe komt u van die klachten af? In veel gevallen kan podotherapie uitkomst bieden.
Vitaal Podotherapie is een moderne éénmanspraktijk in Klaaswaal voor po dotherapie die wordt
gerund door podotherapeut Arjan Zandijk. “Met zorg en aandacht help ik mensen met voetklachten, voet gerelateerde klachten en houdingproblematiek om weer
pijnvrij te kunnen functioneren. Dat helpen gebeurt met de nieuw ste technieken en behandelmetho des zoals een 3D scan-technologie en een analyse van uw stand en looppatroon met behulp van een drukmeetplaat waarbij duidelijk zichtbaar wordt waar normale druk en waar overmatige druk onder de voeten is.



Bij podotherapie denkt iedereen meteen aan het behandelen van voetklachten. Het zoeken naar oplossingen voor die klachten vormt ook het merendeel van ons werk. Platvoeten, holvoeten, of doorge zakte voeten kunnen voor allerlei voetklachten zorgen; voor behan







deling komt de podotherapeut in beeld. Dat geldt ook bij hamertenen, klauwtenen of scheefgroeiende tenen, die voor pijnklachten of onge mak aan de tenen zorgen. Maar een podotherapeut kan vaak ook veel betekenen voor klachten hogerop in het lichaam. Een afwijkende voet stand of een foutief looppatroon kunnen ook aan knieën, heupen en de rug pijnen veroorzaken.
De behandelingen van een podo therapeut bestaan uit het aanme ten van podotherapeutische steun zolen of een siliconen orthese voor om of tussen de tenen, maar ook uit het meegeven van thuisoefenin gen en adviezen zoals een advies

welke schoenen u wel en niet moet dragen bij bepaalde klachten. In veel gevallen worden de kosten grotendeels of geheel vanuit de aanvullende zorgverzekering ver goedt. Om naar een podotherapeut te gaan, is geen verwijzing van de huisarts nodig. In mijn praktijk is iedereen welkom: “Of het nu gaat om een kind, een volwassene of een oudere, iedereen wordt met de zelfde zorg en aandacht begeleid.”
Vitaal Podotherapie

Industrieweg 7B 3286 BW Klaawaal t 085-1305734 e info@vitaalpodotherapie.nl i www.vitaalpodotherapie.nl


































Behangcollecties worden steeds eigenzinniger
Een e en kleurtje, het liefst niet te opvallend. Zo gingen we jarenlang met onze muren om. Heel geleidelijk durfden we meer kleur te kiezen. Nu zetten we met uitbundig behang een stap verder.
En dat kan ook nu de behangcollecties steeds eigenzinniger worden. Ze bepalen met mooie ontwerpen de sfeer in het interieur. We zien het bijvoorbeeld bij Roomblush dat de natuur de woning in haalt met behang dat zorgt voor gezelligheid. Het najaar is de ideale tijd om het interieur weer eens onder handen te nemen. Om je woon-, slaap- of studeerkamer een metamorfose te laten ondergaan. Ook daarbij kun je
eigenlijk niet om behang heen. Heel fraai is de natuurcollectie van Roomblush waar bloemen en planten centraal staan. Denk aan verschillende tinten groen, blauw, roze, terracotta en oker. De elementen in de patronen zijn volumineuzer dan eerdere orale collecties, waardoor de kleuren en de patronen nóg beter tot hun recht komen.
De kinderkamer leent zich bij uitstek voor kleurrijk behang. Met panoramische behang realiseer je
in een handomdraai een geweldige thema-kamer voor je kind. Met grote doorlopende kunstwerkjes, die elk hun eigen verhaal vertellen en de verbeelding stimuleren van je kleine spruit. Met stijlvolle behangprints en bijpassende verfkleuren maak je van elke muur een blikvanger.
Speelse prints maken het huiselijke gevoel compleet. Foto: Roomblush





















Met stijgende energiekosten wordt het energieverbruik een steeds belangrijker criterium. Ondanks een groeiend bewustzijn verbruiken huishoudens nog steeds veel energie. Een deel daarvan kan eenvoudig worden bespaard, zonder aan comfort in te leveren.
Integendeel: moderne technologieën verhogen het welzijn binnen de eigen muren én besparen energie. Iets wat zeker in deze tijd erg belangrijk is. Niet alleen nieuwbouwwoningen kunnen worden uitgerust met Smart Home technologie. Met het GIRA KNX RF systeem kunnen ook bestaande woningen relatief eenvoudig worden omgetoverd tot
Niet iedere droombadkamer is groot
Niet iedere droombadkamer hoeft een grote wellnesstempel te zijn. Het gebruik van passende producten om de beschikbare ruimte optimaal te benutten, opent ook in kleine badkamers allerlei mogelijkheden voor persoonlijke expressie.

Ook in jouw badkamer past een wastafel, douche, toilet en zelfs vrijstaand ligbad. Duravit heeft bijvoorbeeld een portfolio met compacte productvarianten in een scala aan materialen, oppervlakken en kleuren om je persoonlijke feel-good factor te creëren. Met perfecte opties voor compacte ruimtes. Een mooi voorbeeld is het organisch gebogen vrijstaand ligbad Cape God met
ronde vormen en een unieke uweelachtige uitstraling. Een absolute blikvanger. Bijpassende hoge en halfhoge kasten zorgen ervoor dat er in kleine badkamers geen compromissen hoeven te worden gesloten op het gebied van opbergruimte. Wastafels vanaf 420 mm bieden extra opbergmogelijkheden en maken de anders ongebruikte ruimte onder de wastafel bruikbaar.
De feel-good sfeer in de compacte badkamer kan verder worden versterkt door de strategische inzet van subtiele accessoires en planten, evenals het samenspel van uitnodigende lichtbronnen. En kies voor mooie lichte kleuren waardoor het geheel een extra ruimtelijke uitstraling krijgt. Mintgroen is op dit moment erg trendy.
een Smart Home. Dit kan door intelligente en draadloze gebouwbesturing. Daarmee kun je veel functies automatiseren om op deze wijze de belangrijkste functies van een Smart Home te besturen. Denk aan de besturing van licht, zonwering maar ook de temperatuurregeling. Waarom zou je die niet automatisch per ruimte gaan regelen. Dit zorgt voor meer
gemak en wooncomfort, maar het is tegelijk ook een duurzame oplossing die energie bespaart. Bij bestaande en nieuwe woningen die worden uitgerust met Smart Home Technologie, besparen de bewoners aanzienlijk op hun energierekening. Daarnaast ervaren zij een stukje comfort wat het leven iedere dag weer veraangenaamd.































Sinds vorige week exposeren Henny Bos en Vera Bonefaas, beiden uit de Hoeksche Waard, hun schilderijen in de biblio theek aan de Achterstraat 24 in NieuwBeijerland. De expositie duurt tot en met 28 december. Henny en Vera volgen sinds een aantal jaren met veel plezier samen schilderlessen bij Barteljee in Zwijndrecht. Wat ooit begon met naschilderen groeide uit tot eigen vertalingen van opdrachten en ideeën. De onderwerpen zijn divers en variëren van realistisch en impressionis tisch tot abstract. De exposanten werken voornamelijk met acrylverf, soms gebruik makend van en experimenterend met verschillende andere materialen (mixed media). De inspiratie halen zij uit de lessen die zij volgen, exposities en musea die ze bezoeken, dagelijkse dingen. De expositie is gedurende de openingstijden van de bibliotheek vrij te bezichtigen: op dinsdag van 15.30 tot 17.00 uur, op woensdag van 10.30 tot 12.00 uur en van 18.30 tot 20.00 uur en op vrijdag van 18.30 tot 20.00 uur. v.a.
De fietstochten van Doortrappen zijn normaliter tussen de 20 en 25 km en er wordt rekening gehouden met elkaar qua fietssnelheid, want samen fietsen staat voorop bij Doortrappen! In de winterpe riode zal er wat vaker een cultureel of educatief uitstapje gekoppeld worden aan de fietstochten, waardoor de fietstochten iets ingekort worden. De fietstochten zijn om de 14 dagen. Aanmelden voor de fietstochten is niet nodig. Meer informa tie: bianca.denouden@welzijnhw.nl of 06-45653886.
16, 22, 24, 29 november en 1 december Neem een kijkje in de slaapkamer van Sinterklaas
De Sint komt logeren dit jaar logeren in de Herberg van Het Numans-Dorps-huis. Op woensdagmiddag 16 november kunnen de kinderen al een kijkje nemen waar de Sint slaapt in onze herberg. Die woensdag doet de Sint van 16-00-17.00 uur zijn middag dutje, want hij heeft weer een zware avond voor de boeg. Daarna is zijn slaapkamertje te bewonderen op: dinsdag 22, donderdag 24, dinsdag 29 november en donderdag 1 december van 15.00-17.00 uur. Het Numans-Dorps-huis, Buttervliet 1, 3281 LK Numansdorp.
‘Van Verdronken Waard naar Hoeksche Waard’
van klassiek tot pop en alles wat er tus sen zit. De concerten worden gegeven in het kerkje van de Vrijzinnigen Hoek sche Waard aan de Beneden Molendijk 35, 3262 AA Oud-Beijerland. Inloop met koffie/thee van 19.30 - 20.00 uur; concert van 20.00 - ca. 21.00 uur waarna gezel lig samenzijn. Kaarten bestellen via muzikale.ontmoetingen@gmail.com Losse kaarten inclusief alle consumpties kosten € 15, 00 p.p. Een passe partout, voor de 3 concerten, kost € 40, 00. Telefonisch reserveren via 0186 - 612765. In verband met het beperkte aantal zitplaatsen is reserveren noodzakelijk. Bij de ingang worden geen kaarten verkocht.
november
Hulp bij… Sinterklaasgedichten schrijven
De beste dichter ter wereld is Sinterklaas. Maar soms wordt het hem een beetje te veel. Daarom is er hulp bij het maken van gedichten in het Oude Raadhuis te OudBeijerland. Op vrijdagmiddag 18 novem ber van 14 tot 16 uur geeft de bibliotheek een helpend handje. Motto: rijmen is goed, maar dichten is leuker. Kom op vrijdag middag 18 november om 14 uur naar de bi bliotheek in het Oude Raadhuis en schrijf zelf een gedicht met de gedichtenhulp van de bieb. Het is gratis maar vooraf aanmel den is noodzakelijk. Dat kan via de website www.debhw.nl/agenda of bij de balie van de bibliotheek.
ken die u zullen verrassen, ontroeren maar ook laten lachen: eenakters met de namen “niets”, “Leve de koning” en “De inbreker”. De voorstellingen vinden plaats in de kleine zaal van het voormalig Actief College aan de Koninginneweg 126 in Oud-Beijerland. Aanvang: 20.00 uur (zaal open: 19.30). Kaarten €10- via kaarten@toneelgroepmask.eu of aan de zaal. Meer info: toneelgroepmask.eu 18 en 19 november
In Galerie De Opkamer, Merwedestraat 21, Maasdam kunt u vanaf heden een nieuwe expositie met werk van Nathalie Couret bekijken. Nathalie Couret haar creatieve ontwikkeling en liefde voor de kunst begon in het Zuiden van Frankrijk. Haar aandacht werd daar getrokken door het landschap, de rivieren en de kleuren. Haar werk getuigt van krachtige personages. Vrouwenfiguren die kracht, schoonheid en zuiverheid uitstralen. Die verhalen te ver tellen hebben. Verhalen in de context van harmonie, kleuren, strakheid, puurheid en romantiek. Nathalie is op zoek naar perfectie en het mysterie achter de vrouw. De expositie duurt tot eind decem ber en is op afspraak te bezoeken. Eelse Bies: 06-38928155

Op woensdag 16 november heeft de goedheiligman in zijn drukke agenda tijd gemaakt om de bibliotheek in OudBeijerland en de markt te bezoeken. Sinterklaas is erg nieuwsgierig hoe zijn voormalig ‘Huis van Sinterklaas’ veran derd is en komt op 16 november om 10.30 uur en 14:15 uur dan ook graag langs om de kinderen voor te lezen. Dan is het feest nog niet voorbij, want de kinderen kun nen nog lekker even knutselen en koekjes versieren in het MaakLokaal. Sinterklaas zal die dag ook de weekmarkt bezoeken voor een fotoshoot en een gezellig praatje. De markt deelt kleurplaten uit en de kinderen krijgen iets lekkers als ze deze weer mooi ingekleurd komen inleveren. www.bibliotheekhoekschewaard.nl
Lekker Doortrappen in november Ook in november zijn er weer fietstoch ten van Doortrappen. Woensdag 16 en 30 november vanaf 9.00 uur bent u van harte welkom in The Point, Sportlaan 6 in Puttershoek voor een kopje koffie of thee en om 9.30 uur start de fietstocht.
Willy Spaan, redacteur en medeschrijver van het boek De Canon van de Hoeksche Waard, geeft op donderdagavond 17 november een lezing in Museum Hoeksche Waard in Heinenoord over de ondergang van de Groote Waard en het ontstaan van de Hoeksche Waard. In de nacht van 17 op 18 november 2022 is het precies 601 jaar geleden dat de Groote of ZuidHollandsche Waard in 1421 door de Sint Elisabethsvloed is verdronken. Voor Willy Spaan een mooie gelegenheid om deze vrij onbekende streekgeschiedenis in een lezing te herdenken. Aanvang 19.30 uur in Locatie ‘t Hof van Assendelft, Hofweg 13, Heinenoord. Reservering van zitplaat sen en toegangskaarten à € 10, - nood zakelijk via: www.museumhw.nl of via info@museumhw.nl of tel. 0186 - 60 15 35.
18 november
Samen eten in de Roze Salon 18 november is het weer zover! Er is weer Roze Salon in de Open Hof. Dit keer geen vrijdagmiddagborrel, maar een gezellig diner tussen 17.00 uur en +/- 19.00 uur. Tijdens dit leuke initiatief van Roze 50+, Welzijn Hoeksche Waard en de Open Hof zijn 50+ LHBTI-ers, hun buren, vrienden of familie en iedereen die geïnteresseerd is van harte welkom in de huiskamer van de Open Hof aan de W. van Vlietstraat 2a in Oud-Beijerland. We vragen dit keer een bijdrage van €2, - p.p. en meld je via de mail even aan en vermeldt of er dieet-zaken zijn die we moeten weten: Linda.vanderwal@welzijnhw.nl Overige vragen kun je stellen aan roze50plus@janderksen.nl
18
Oud-Hollandse liedjes zingen Elke derde vrijdag van de maand zingen ze in het Odensehuis om 14 uur Oud-Hol landse liederen en meer, onder muzikale begeleiding van Lianne. Altijd weer een feest om mee te maken. U bent van harte welkom om mee te zingen en/of te luis teren in Odensehuis Hoeksche Waard in Boezem & Co, aan de Boezemsingel 7 in Oud-Beijerland. Voor meer info: 06-12892309 of info@odensehuishw.nl
Goed voorbereid
Vind je het ook zo lastig om een surprise te maken en weet je niet hoe je moet beginnen? Wil je dit jaar goed uit de verf komen met iets wat jezelf gemaakt hebt? Wil je een keer iets anders maken dan anders? Kom dan naar het Hoeksch MaakLokaal. Op 18 en 19 november zijn er inloopmomenten waar hulp en praktische tips gegeven worden voor het maken van een persoonlijke surprise. Op vrijdag 18 november: 14.00 tot 16.00 uur en zaterdag 19 november: 11.00 tot 16.00 uur. Voor het gebruik van materialen wordt een kleine bijdrage gevraagd van € 4, 20 (plusabon nement), € 5, 10 (basisabonnement) of € 6, - (niet-leden). Je betaalt dit bedrag per surprise. Voor grote objecten die op ver zoek uit hout uitgesneden worden of met de 3D-printer worden uitgeprint en grote stickers, wordt de kostprijs in rekening gebracht. Deze kun je terplekke beta len. Deze activiteit is geschikt voor alle leeftijden. Aanmelden is noodzakelijk via www.bibliotheekhoekschewaard.nl Adres: Waterstal 1 in Oud-Beijerland.
18, 22, 25, 29
Op dinsdag- en vrijdagmiddag kunt u in het sfeervolle Korstanjehuis (Oranjeplein 34) terecht voor een recreatief potje klaverjas en/of biljart. Niveau is niet zo belangrijk. Gezelligheid is waar het om gaat. Kom gerust eens een keertje kijken. Dinsdag en Vrijdag tussen 13.30 uur en 16.30 uur. Er wordt alleen een kleine bijdrage gevraagd voor de koffie. Meer in formatie: Linda.vanderwal@welzijnhw.nl 06-82848467.
Het buurthuis MeMekaer Kerkstraat73 in Strijen is vrijdagmiddag de plek waar mannen/heren vanaf 14.00. tot ca. 16.00 uur welkom zijn voor een ontmoeting met koffie/thee. Naast een praatje en uitwis seling van gezellige zaken is er regelmatig een presentatie met verschillende interes sante onderwerpen. Opgeven is niet nodig.
Een nieuwe serie muzikale ontmoetin gen wordt 17 november gestart met een concert door Duo di Alloro. Twee uiterst muzikale jeugdige talenten t.w. Julian van der Linden (2001) en Daphne Wesseling (1998), waarvan de eerste geboren is in Oud-Beijerland. Beiden hebben inmid dels een indrukwekkend muzikaal C.V. Het enthousiaste duo treedt op onder de naam “Duo di Alloro” en bespeelt vrijwel het gehele scala van saxofoons. Met behulp van de moderne techniek kunnen zij zelfs een kwartet of ensemble vormen. Het repertoire is veelzijdig en varieert

Vrijdag 18 november 14.00 uur is er in het buurthuis MeMekaer, Kerkstraat 73 Strijen de interactieve presentatie “Goed voorbereid” door het Rode Kruis. Ben jij goed voorbereid wanneer er in je buurt of dorp een grote of kleine ramp plaats vind. Een ramp hoeft niet altijd heel groot te zijn. Wat doe je als je plotseling je huis uit moet of misschien helemaal niet naar bui ten mag. Hoe kan je, je daar op voorberei den? Vrijwilligers van het Rode Kruis gaan dan op een educatieve wijze aan de slag om je hierover te informeren. Je ontdekt hierbij hoe bij jou thuis de stand van zaken is en wat je kan veranderen om veilig uit een benarde situatie te komen.
18 en 19 november
Eenakterfestival Mask Op 18 en 19 november a.s. speelt toneel groep Mask speelt drie korte theaterstuk
Op zaterdagmiddag 19 november a.s. is om 15.00 uur het domineesconcert in de Gereformeerde Gemeente Puttershoek: De Levensbron, Sportlaan 2a. Het concert wordt door drie predikanten gegeven, Ds. G.J. Baan (Rotterdam - Zuidwijk), Ds. M.J. Schuurman (Oldebroek) en Ds. C.J. Droger (Vlaardingen). Het concert wordt afgesloten met een improvisatie, aanslui tend samenzang. De toegang is gratis, aan de uitgang zal worden gecollecteerd voor het bouwfonds.
Op zaterdag 19 november vanaf 10.0014.00 uur wordt er in de Greupkerk, Stougjesdijk 208 te Oud-Beijerland, een 2e handsboekenverkoop én najaarsmarkt gehouden. Er is weer een nieuwe aanwas boeken. Vooral de collectie kinderboeken
Muzikale ontmoeting met “Duo di Alloro”
















































































zijn aangevuld. In de kerkzaal zullen weer allerhande spullen verkocht worden die vooral met het najaar en de winter te maken hebben. Kom gezellig langs om alvast cadeautjes voor de feestdagen aan te schaffen.
Op 19 november om 10.30 uur arriveert Sint met Tuk Tuk in het centrum van Strijen. Van 10.30-12.30 uur rijden Sint en zijn Pieten van het Spui , door de Boom pjesstraat, naar de Kerkstraat, door naar de Kaai en door de Oranjestraat. Sint en Pieten rijden door het dorp om alle kinderen te begroeten. In de Kerkstraat bij kinderboekwinkel Mijn Eiland speelt een accordeonist Sinterklaasliedjes en bij DB Mode zullen Pieten een poging Spijker broekhangen gaan doen.

Een goed boek brengt gesprekken op gang en verbindt lezers met elkaar. Daarom geeft de Bibliotheek Hoeksche Waard de gehele maand november in het kader van ‘Nederland leest’ het boek Mevrouw, mijn moeder van Yvonne Keuls cadeau. Nederland Leest 2022 gaat over het ouder worden in deze tijd: we worden met z’n allen gemiddeld steeds ouder, maar we blijven ook steeds fitter. Hoe word je op een fijne manier ouder? En hoe zorg je ervoor dat je in elke levensfase contact houdt met je medemens? Op dinsdag avond 22 november is er om 19.30 uur een online leeskring over Mevrouw, mijn moeder. Lezers gaan met elkaar online in gesprek over dit aangrijpende boek. Voor mensen die moeite hebben met lezen gaan we donderdag 24 november van 13.3015.00 uur in de salon in het Oude Raad huis samen het boek lezen. We gebruiken hiervoor de speciale editie in gemakkelijke taal. Aanmelden voor de online leeskring op 22 november 19.30-21.00 of het samen lezen op 24 november 13.30-15.00 uur in Oud-Beijerland kan via de agenda van de bibliotheek ( bibliotheekhoekschewaard.nl) of bij de balie in de bibliotheek. Deelname is gratis.
22 en 24 november, 13 december Workshops SISKW
Er zijn nog plaatsjes vrij voor de workshop “Boomstam lamp maken” op dinsdag avond 22 november en de workshop ‘Potten bakken op 24 november. Op 13 december kan je de workshop “Kerstkrans maken” volgen. Wil je aan één van deze workshop meedoen, graag aanmelden via www.siskw.jimdo.com of via ons telefoon nummer: 06-15444775
als dat mogelijk is. Deze activiteit is ge schikt voor 12 jaar en ouder. Indicatie van de kosten zijn € 6, - voor een tasje met een kort hengsel en € 6, 50 voor een tasje met een lang hengsel met een opdruk van 20 cm groot. De totale kosten zijn afhankelijk van de precieze grootte van de opdruk, dus je rekent het tasje aan het eind van de workshop ter plekke af. Graag wel vooraf opgeven via bibliotheekhoekschewaard.nl
Bibliotheek Oud-Beijerland Centrum | Waterstal 1 | Oud-Beijerland 23 en 25 november
18.30 uur. De bezoekers zijn vanaf 19.00 uur welkom.
Op zaterdag 19 november is het zover, de eerste Canicross van de Hoeksche Waard! Het is een hardlooptraject die je samen met je hond loopt. Je kan kiezen uit 2, 5 en 5 KM en loopt hem op jouw eigen tempo (of dat van jouw hond). AniCura Dieren ziekenhuis Stroowaert organiseert deze unieke loop i.s.m. AV Spirit in Oud-Beijer land. Heb je geen hond? Geen probleem, ook dan kun je meedoen. Je adopteert dan een knuffelhond van Hulphond Nederland en steunt daarmee direct het goede doel. Start en finish is bij AV Spirit, Langeweg 14, Oud-Beijerland. Het parcours is bijna geheel onverhard. Voor meer informa tie en inschrijven ga naar onze site: www.stroowaertcanicross.nl

Cybernetwerk Zuid Hollandse Eilanden organiseert op 21 november een online cyber talkshow voor ondernemers. In navolging op de drie fysieke cybercrime congressen die Cybernetwerk ZHE eerder dit jaar organiseerde. Doel van deze congressen was om bewustwording te creëren bij de lokale ondernemers over de risico’s en gevaren van cybercriminaliteit. Nu staat centraal “Welke vragen kunnen/ moeten ondernemers stellen aan hun IT-expert om de veiligheid op het gebied van cybercriminaliteit te verbeteren.” Aan de talkshowtafel zullen plaatsnemen om hun kennis en ervaringen te delen: Marcel Boer, financieel directeur van Hoppen brouwer Techniek wat slachtoffer werd van een cyberaanval, cybercrime expert Erik de Jong van Fox-IT en de voorzitter van de OHW, Frank van den Ouden. Ewout Genemans is opnieuw de gespreksvoorzit ter. De online cyber talkshow vindt plaats op maandag 21 november van 10.00 -11.00 uur en zal live worden uitgezonden. Via de website www.cybernetwerkzhe.nl kun je je aanmelden om de talkshow gratis te volgen. Je ontvangt na aanmelding een link naar een streaming.
23 november
Sintmiddag in Odensehuis
Frisse wind door je bits en bites In november zijn er twee workshops van het DigiTaalhuis Hoeksche Waard in de bibliotheek over opschonen en een frisse wind door smartphone, tablet of laptop. Zo blijft apparatuur lekker snel. Is de PC traag? Komen er rare foutmeldingen? Een onderhoudsbeurt doet wonderen. Haal de bezem erbij en schoon de computer op. Geen zin om zelf de PC of tablet te ontdoen van overbodige bestanden? Laat Win dows 10 automatisch dat soort bestanden verwijderen. Een foutje maken is niet erg. Wie iets te snel op de Delete-toets drukt, kan het altijd terugzoeken. Is het bestand per ongeluk verwijderd? Weet waar het terug te vinden is. Op 23 november (Biblio theek Strijen) en 25 november (Bibliotheek Oud-Beijerland) zijn er workshops over het opschonen van tablets, laptops, smart phone of pc’s. Meld je aan via de website www.debhw.nl/actueel/agenda of gewoon bij de balie in de bibliotheek. Woensdag 23 november 10 uur tot 12 uur | Bibliotheek Strijen | Stockholmplein 6 | 3291 TP Strijen | Vrijdag 25 november 10.15 tot 12.15 uur | Bibliotheek Oud-Beijerland | Waterstal 1 | 3262 JR Oud-Beijerland | Toe gang € 2, 50 voor plusleden, € 3, 00 voor leden en € 3, 45 voor niet-leden
De ‘s Gravendeelse IJsclub organiseert op 26 november de 13e editie Seuterwin ter wandeltocht. Er zijn routes van 5, 10, 15, 20, 30 en 40 kilometer. De routes zijn bepijld. Op 26 november kun je je bij de ‘sGravendeelse IJsclub inschrijven. Vooraf inschrijven op de site is mogelijk voor groepen, maar niet verplicht. De kantine is geopend van 7.30 tot 17.00 uur. Ook belangstellenden zijn welkom! De koffie staat klaar! Routes en GPX zijn vanaf 24 november 2022 te downloaden via de web site. Inschrijvingskosten: Niet leden: €4, 00 Leden IJsclub en KNWB: €3, 50
Bij deze workshop van Plukhoek Mook hoek maak je een krans van wilgenkatjes. (16.00 uur-17.30 uur). We gaan werken met eucalyptus, rozenbottel, jeneverbes, hypericum, IJslands mos, appeltjes en dennenappels. De krans kan opgemaakt worden om te hangen of neer te leggen. Prijs: €29, 75. Boeken: www.plukhoekmookhoek.nl/ product/workshop-krans-vanwilgenkatjes-26-11/
“Dorffest im Koningshoeve” Op zaterdag 26 november a.s. organiseert Die Alpenjäger uit Klaaswaal de eerste editie plaats van “Dorffest im Konings hoeve”. Je wordt door de muzikanten meegenomen op een muzikale reis met originele Egerländer en Böhmischemu ziek. De klassiekers afgewisseld met nieuwe muziek en solostukken staan ga rant voor een leuk, afwisselend muzikaal programma. Ook DJ Alex is aanwezig voor lekkere dansmuziek. Tijd: vanaf 19.00 uur Locatie: De Koningshoeve - Klaaswaal Entree: € 7, 50 incl. drankje Reserveren: info@diealpenjager.nl
Sint Nicolaas heeft zijn intrede gedaan in Nederland. Trio Ackoord komt in het Odensehuis om dit te vieren. Helaas heeft de Goed Heiligman geen tijd om een bezoek te brengen aan ons, maar een van de pietermannen zou ons weleens aangenaam kunnen verrassen met een bliksembezoekje. Vol verwach ting klopt ons hart ….. Aanmeldingen: coordinator@odensehuishw.nl of 0612892309 of loop gewoon gezellig binnen! Odensehuis Hoeksche Waard in Boezem & Co, aan de Boezemsingel 7 in OudBeijerland.
23 en 25 november
Workshop Bedruk een linnen tasje Iedereen die een mooi persoonlijk cadeau wil geven met de feestdagen kan deze leuke workshop volgen op woensdag 23 en vrijdag 25 november van 14.30 - 16.30. Ge leerd wordt hoe een linnen tasje van een mooie persoonlijke boodschap kan worden voorzien. Bij deze workshop wordt gebruik gemaakt van de vinylsnijder en heatpress. Neem een eigen laptop en USB-stick mee
Oud-Beijerland Centrum organiseert Love the Lights: Lichtfeest op vrijdag(avond) 25 november a.s. van 19.00-21.00 uur. Dit is een event waarbij alles draait om licht. Hierbij worden metershoge lichtobjecten geplaatst en aangezet in het centrum. Er komt een lichtshow geprojecteerd OP het raadhuis (start 19.00 uur), er komen grote ballonnen met licht erin op de Vliet en er wordt gezorgd voor muziek en straatar tiesten.

VV Strijen organiseert op vrijdagavond 25 november weer een Bingo. Aanvang 20.00 uur. Een gezellig avondje uit met kans op mooie prijzen. Eerste kop koffie of thee gratis. 10 ronden voor € 10,00. Ieder extra boekje € 5,00. Betaling contant! Kantine open 19.00 uur. Adres: Sportlaan 10 Strijen
Op vrijdag 25 november organiseren wij een speelgoedbeurs van 19.00-22.00 uur in de foyer van ons Numans-Dorps-huis, Buttervliet 1 in Numansdorp. Je kan een tafel huren voor € 5 en jouw overbo dige speelgoed verkopen. Kijk even op www.numansdorpshuis.nl om je aan te melden of bel gewoon ons HUIS 0186685729). Het is de bedoeling dat je een half uur van tevoren aanwezig bent, dus om
Meet and greet met Sint en Pieten Op zondag 27 november van 14.00-16.00 uur kunnen de kinderen Sint en zijn Pieten ontmoeten en gelijk een kijkje nemen in zijn slaapkamertje in de herberg van Het Numans-Dorps-huis. De kinderen kunnen ook een mooie kleurplaat inkleuren en een pietendiploma halen. Adres: Buttervliet 1, 3281 LK Numansdorp
28
Dochters en zonen van mensen met dementie
Deze bijeenkomsten zijn één keer in de maand in het Odensehuis, op de maan dagavond van 19-21.30 uur. Deze keer maken wij dementie mee, door de ogen van de ouder met dementie. Dit met gebruik van de Virtual Reality bril. Wilt u ook gebruik maken van deze bijeen komsten, dan kunt u zich aanmelden via coordinator@odensehuishw.nl of 06-12892309. Ons adres is Odensehuis Hoeksche Waard in Boezem & Co, aan de Boezemsingel 7 in Oud-Beijerland.
Op woensdag 30 november is er ook een gezellig Sinterklaasfeest in de bibliotheek van Oud-Beijerland. Om 10.30 uur en om 14.30 uur wordt er voorgelezen, koekjes versierd en lekker geknutseld in het Maak Lokaal. Deze activiteiten zijn geschikt voor alle leeftijden, echter in de ochtend is het verhaaltje gericht op kleine kinderen tot 4 jaar, terwijl in de middag de wat grotere kinderen aan de beurt zijn.












Aanmelden voor het voorlezen en knutselen kan via de agenda op www.bibliotheekhoekschewaard.nl . Kos ten: €1,70 met een plusabonnement, €2,10 met biebpas en €2,45 zonder biebpas.
Bingo Korstanjehuis
1 december kan er in het Korstanjehuis in Klaaswaal weer gezellig bingo gespeeld worden. De bingo vindt plaats tussen 14.00 uur en 16.00 uur en de kosten zijn €6, 50 inclusief koffie/thee. Vooraf aanmelden is niet nodig. Voor meer informatie over de activiteiten van Welzijn Hoeksche Waard in het Korstanjehuis kunt u bellen met Linda van der Wal, 06-82848467.
Op vrijdag 2 december van 16.00-22.00 uur wordt een winterfair georganiseerd in Het Numans-Dorps-huis, Buttervliet 1 in Numansdorp. Standhouders verkopen dan hun zelfgemaakte originele producten.
campagne. Om dit beeld terug te roepen komt de “Stichting Oud-Puttershoek” op zaterdag 3 december met de tentoonstel ling “De Zoete Geur van de Peefabriek”, met veel foto’s en voorwerpen. Ook wordt de film “De Peemeule” vertoond, met deze film kunt u het productieproces volgen van biet tot suiker. Van 10 tot 16 uur in het Jaap Hoogvliet-museum, Kastanjelaan 2 te Puttershoek.
Zaterdag 3 december brengt Sinterklaas opnieuw een bezoek aan het centrum van Numansdorp. Van 14.00-16.00 uur wandelt de Goedheilig man door de winkelstraten en begroet hij de kinderen.
Repair Café ‘s-Gravendeel
IJslands mos, dennenappels en kerst groen. Kom ook in de stemming en ga voor dit sfeervolle maar niet moeilijke stuk bij Plukhoek Mookhoek. Gezellig bijkletsen en toch creatief bezig zijn met de duurzame materialen uit onze boomgaard. Van 19.00 uur- 20.30 uur. Kosten: €32, 50 Opgeven via www.plukhoekmookhoek.nl
en weten we hoeveel mensen er komen. www.wereldlichtjesdaghoekschewaard.nl 12 december
Herensoos De Drie Lelies
Maandag 12 december is er van 14.00 uur tot 16.00 uur weer een bijeenkomst van Herensoos De Drie Lelies gepland in ac tiviteitencentrum De Drie Lelies, Narvik straat 1 in Puttershoek. U bent van harte welkom voor een kopje koffie, een goed gesprek en regelmatig wordt er een lezing, presentatie of excursie georganiseerd. Nieuwsgierig geworden, kom gezellig op de koffie! De bijeenkomsten van de Heren soos zijn elke 2 e maandag van de maand. Aanmelden van tevoren is niet nodig. Voor meer informatie kunt u contact opnemen met Bianca den Ouden van Welzijn Hoek sche Waard: 06-45653886 of mailen naar: bianca.denouden@welzijnhw.nl
in het Odensehuis
Van 10.30 tot 12.00 uur vindt de gespreks groep plaats voor partners van mensen met geheugenverlies en (beginnende) de mentie. Hier worden ervaringen gedeeld en tips uitgewisseld o.l.v. Lianne van Dam. Samen delen ondersteunt en verbindt. Er is nog ruimte in deze gespreksgroep voor nieuwe deelnemers. Wilt u vrijblijvend een keer langskomen om te ervaren hoe deze bijeenkomst bij u past? U bent van harte welkom. Een vrijwillige bijdrage stellen wij graag op prijs. Voor meer informatie: info@odensehuishw.nl of 06-12892309. Odensehuis Hoeksche Waard in Boezem & Co, aan de Boezemsingel 7 in OudBeijerland.
2 december
Sintliedjes zingen in Odensehuis
Vandaag komt Frans de Nooij om met ons Sint Nicolaasliedjes te zingen, dus loop gezellig binnen. Frans speelt piano en wie wil, zingt of luistert mee en geniet van de gezelligheid, want in het Oden sehuis kent dit geen tijd. Piet komt met een zak vol lekkers, vooral voor wie zoet is geweest, zoals Lianne uit het boek van Sint leest. U bent van harte welkom in Odensehuis Hoeksche Waard in Boezem & Co, aan de Boezemsingel 7 in OudBeijerland. Voor meer info: 06-12892309 of info@odensehuishw.nl
Op zaterdag 3 december is het Repair Café ‘s-Gravendeel weer geopend van 10.00 uur tot 12.00 in het Trefpunt in Verzorgings huis ‘Immanuel’ Weegje 1 in ‘s-Gravendeel. Hier kunt u uw defecte goederen en apparatuur, huishoudelijk of anderszins ter reparatie aanbieden evenals kleding en overige textiel. De vrijwilligers heten u van harte welkom. De koffie staat klaar. Een vrijwillige bijdrage wordt zeer op prijs gesteld.
Kerstmarkt De Melkbus
Op zaterdag 3 december houdt Kringloop winkel de Melkbus aan de Oranjestraat 2b in Heinenoord van 10.00 - 16.00 uur een kerstmarkt. Gelet op de datum kunt u uiteraard ook terecht voor de laatste, vergeten, sinterklaasinkopen. De markt is zowel in als rond het pand. Voor de inwen dige mens wordt ook goed gezorgd.
Gezond Natuur Wandelen vanaf Klein Profijt
Zondag 4 december is er weer een wan deling van Gezond Natuur Wandelen vanaf Klein Profijt. Kom ook een uurtje wandelen samen met andere mensen, in een rustig tempo, begeleid door vrijwil ligers die onderweg iets vertellen over de natuur en/of de omgeving en na afloop van de wandeling een kopje koffie of thee drinken. Dat is Gezond Natuur Wande len! Start om 15.00 uur bij Klein Profijt aan het Zalmpad 11 in Oud-Beijerland. Aanmelden vooraf is niet nodig. Meer info: Bianca den Ouden 06-45653886 of bianca.denouden@welzijnhw.nl
Verkoop kerststukjes voor ‘t Huys te Hoecke en Korenschoof Op 8 en 9 december a.s. worden door vrij willigers van de Stichting Vrienden van ‘t Huys te Hoecke en Korenschoof kerststuk jes gemaakt. Er zijn kerstukjes in allerlei soorten en maten. De opbrengst hiervan is voor de stichting die het geld besteedt aan de bewoners om daarmee zaken aan te schaffen of diensten te verlenen die niet uit de overheidssubsidie die Zorgwaard krijgt, betaald kunnen worden. De verkoop van kerststukjes is op 9 december locatie ‘t Huys te Hoecke te Puttershoek van 14.00 - 19.00 uur en mochten er nog stukjes over zijn, dan worden die op 10 december vanaf 10.00 uur verkocht.
Kerst van alle tijd Een beleving, uitgevoerd door HW Vokaal o.l.v. Hans Matla. Naast het koor wordt medewerking verleend door een verteller en solisten, met begeleiding van syn thesizer, piano, fluit en combo. Locatie: Evangelische Gemeente Hoeksche Waard (EGHW) / De Poort, Polderlaan 1, OudBeijerland. De zaal gaat open om 19.30 uur. Aanvang:20.00 uur. Prijs: € 17, 50
Kerstmarkt Westmaas De Protestantse gemeente Nieuwland houdt op zaterdag 10 december a.s. in het kerkelijk centrum De Munnik weer haar kerstmarkt. Dat is van 10.00 tot 15.00 uur.
Op deze kerstmarkt zijn o.a. te koop fraaie kerstukjes, erwtensoep, stoofperen, jam, kerstkaarten en kerstartikelen. Daar naast is er een verloting waarmee leuke prijsjes te winnen zijn.
11 december
Wereldlichtjesdag
Kerststukjes maken met Rosa en Mayke, voor thuis of om cadeau te geven. Inclusief materiaal betaalt u 5 euro. U bent van harte welkom in Odensehuis Hoeksche Waard in Boezem & Co, aan de Boezem singel 7 in Oud-Beijerland.
16 december
Tentoonstelling
De herfst stond vroeger in Puttershoek altijd in het teken van de suikerbieten

Alle ecologische ingrediënten voor een klassiek kerststuk met een knipoog zijn aanwezig; sneeuwbes, hulst, eucalyptus,
Op de 2e zondag in december is het Wereldlichtjesdag. In diverse plaatsen in Nederland vinden bijeenkomsten plaats. In de Hoeksche Waard is de bijeenkomst in De Open Hof, W. van Vlietstraat 2a, Oud Beijerland. Om 18.30 uur start de bijeenkomst en om 19.00 uur wordt voor ieder overleden kind een kaarsje aange stoken. Om 19.45 uur is het einde van de bijeenkomst waarna er de gelegenheid is om na te praten met koffie/thee en wat lekkers. Het is fijn als je je vooraf aanmeldt. Dan staat er een kaarsje klaar
Het begon als een lolletje zo’n kwart eeuw geleden: Hetty Bervoets dirigeerde al een aantal jaren een paar koren in de Hoeksche Waard en ook het kinder-en tienerkoor “De Put tertjes” in Puttershoek.
De moeders van dat kinder- en tiener koor wilden zelf ook wel eens zingen en zo werd in novem ber 1997 de eerste repetitie van dameskoor Tuesday-Tunes gehou den. Het koor repeteert op dins dagavond, vandaar dat deze naam verzonnen is door de beheerders
Henry en Ineke de Krom. Het repertoire van het dameskoor is zeer gevarieerd. Er worden nummers uit musicals gezon
gen, maar ook popnummers en Nederlandse muziek staan op hun programma. Alle muziek wordt door Hetty zelf gearrangeerd.

De dames zingen dan ook van bladmuziek... Het schrijven van de arrangementen is veel, maar erg leuk werk en wordt met liefde door Hetty gedaan. Bart-Jan van der Linden is al jaren de vaste pianist van de Tuesday-Tunes.
De grootte van het koor varieert nogal eens in de loop van de jaren. Dus heb je ook zin om te zingen in een gezellig dameskoor? Bel dan met Hetty Bervoets op 078 6744268. Uiteraard staan kwaliteit en plezier in het zingen voorop bij de Tuesday-Tunes dames, maar gezelligheid is ook belangrijk!
Kerstconcert Pop-Up koor Op vrijdagavond 16 december a.s. or ganiseert de Stichting Vrienden Dorps kerk Westmaas een Kerstconcert in de Dorpskerk van Westmaas dat wordt gegeven door Pop-Up. Sinds de oprichting in september 2001 is Pop-Up uitgegroeid tot een bijzonder én semiprofessioneel popkoor dat geweldige optredens op haar naam heeft staan! Pop-Up heeft onder leiding van dirigente en zangpeda goge Inge Rambags opgetreden tijdens culturele evenementen en korenfestivals, op feesten en bij bijzondere gebeurtenis sen. Het repertoire is zeer gevarieerd en bevat vele Top 2000 nummers. De toegangsprijs voor deze benefietavond bedraagt € 10, 00 p.p. Aanmelden kan via www.vriendendorpskerkwestmaas.nl of bel 0186-571797. Het concert begint om 20.00 uur en vanaf 19.30 uur is de kerk open.
De kringloopwinkel van stichting de Overbrugging is verhuisd naar een nieuwe locatie. De nieuwe win kel is aan de Willem Beukelszstraat 6a, Oud-Beijerland. Dat is nabij de winkelboulevard op industrieter rein de Bosschen. De winkel is geopend op woensdag, vrijdag en zaterdag van 10.00-16.00 uur. De tweede etage van de winkel is ook per lift bereikbaar. Inleveren van goederen doet u aan de achterzijde van de winkel op woensdag en vrijdag tijdens openingstijden van de winkel.
tribute concert en een top 2000 ‘live’ act. Bezocht u de culturele Week in Ooltgensplaat nog niet eerder? Met veel plezier en enthousiasme begroeten de organisatie, medewerkers en artiesten u tijdens deze dagen in Ooltgensplaat. Donderdag 24 november Zaal open 19.00 uur - Aanvang 20.00 uur “PODIUMBEEST

het jaar 1876











heeft


de
voorstellingen
Het
krom en versleten en wil hij eindelijk op weg naar de uitgang. Mocht hij die vinden, dan is hij vastbesloten de deur met een onvergetelijke KNAL achter zich dicht te smijten. Het zal niet onopgemerkt blijven! Maar gaat hem dat lukken? En zal dit solitaire zoogdier ook buiten zijn veilige leefgebied kunnen overleven, met weet ik hoeveel mensen met een jachtvergunning? Podiumbeest ontsnapt! mag dan het allerlaatste cabaretprogramma van Mark van de Veerdonk worden, zijn handelsmerk blijft hetzelfde: een overdosis aan oneliners, anekdotes en prettig gestoorde meningen op een zalige hoop gegooid. En dat alles met zowaar een rooie draad! Ook in dit programma jakkert de Brabander





Ze waren legendarisch, de hapjes en het eten van het gastronomische ‘Live Cooking Buffet’, op zaterdag en zondag in Alcazar. Hoeveel duizenden hebben er niet onbeperkt van genoten in de elf jaar dat de gebroeders (Jacob, Leen en JanWillem) Streefkerk Alcazar Events aan de Groeneweg in Puttershoek runden. De all-you-can-eat formule sloeg aan. Tot het ineens voorbij was, in september vorig jaar. Corona gooide roet in het eten voor een daverend slotfeest in de voormalige discotheek, die plaats maakt voor woningbouw. Het was ineens over en uit…
Maar niet voor Jan-Willem, de jongste van de drie die al die tijd als chef-kok fun geerde en die horendol werd van het nietsdoen in coronatijd. Sinds zijn 15e werkte hij al in de keu ken; het koks vak leerde hij in De Wijnzolder, het restaurant boven de bowlingbanen van De Posthoorn aan het Schouteneinde. En dan niks om handen hebben... Dus startte
hij samen met zijn vrouw Bianca al vanuit Alcazar een maaltijd be zorgservice. Alcazar At Home was daarmee geboren.
Toen Alcazar dicht ging, ging het echtpaar daarmee verder. Vanuit huis aanvankelijk: eenvoudige maaltijden van verse producten, zoals stoofschotels en stampot ten, terwijl er meteen ook al 3- en 4-gangenmenu’s konden worden besteld en een heerlijke high-tea of
een borrel box tot de mogelijkhe den behoorden. Daarmee herleef den de Alcazar-hapjes als het ware op het bord. Catering op een bedrijf of aan huis kon ook.
Intussen werd driftig gezocht naar een definitief onderkomen. Het bedrijventerrein aan de Boonsweg was aanvankelijk een optie. Uitein delijk werd het een bedrijfsverza melgebouw aan de Smaragd op het bedrijvenpark Dordtse Kil III, net voorbij de Kiltunnel. Ook groot handel Makro en het uit Strijen verhuisde kantoor en magazijn van De Bommel Meubelen hebben daar een plek gekregen.
Maar de bouw duurde langer dan voorzien en zodoende moesten Jan-Willem en Bianca meer dan een jaar hun eigen keuken gebruiken om alle bestelde maaltijden te be reiden. En dat is best een ding, ver tellen ze, als je dat tien weken lang moet doen voor de 130 Oekraïense vluchtelingen die in het voorma lige gemeentehuis in Piershil zijn opgevangen en vervolgens ook nog eens zes weken lang, zeven dagen per week, voor de Oekraïners die onderdak kregen in het gemeente
huis in Strijen. Maar op zaterdag 5 november konden Jan-Willem en Bianca met familie, vrienden en bekenden dan toch de officiële opening vieren van het nieuwe bedrijfspand, waarin overigens een deel van de keukeninventaris van Alcazar een plekje heeft gekregen.
Jan-Willem (58): “We bezorgen heerlijke maaltijden aan huis in de hele Hoeksche Waard, de Drecht steden en in Barendrecht, maar niet zoals iedereen dat doet. Bij ons zijn de gerechten voor 90 procent af en doe je de laatste 10 procent zelf. De gerechten zijn zo voorbe reid dat je binnen enkele hande lingen een top-diner op tafel kunt zetten voor jezelf en voor je gasten. Het enige wat je nodig hebt is een pan met warm water, een oven en een airfryer of frituurpan.”
En: “De voorgerechten worden aangeleverd zonder dressing erop. Ook zijn de nagerechten zo goed als klaar, behalve de sausjes en garni tuur. Maar dankzij onze gedetail leerde en complete uitleg kan zelfs de grootste ramp in de keuken met onze drie- en viergangen menu’s uit de voeten.” Er staan wisselende gerechten op de menukaart. Een menu bestaat per persoon uit 5 voorgerechtjes, een hoofdmenu in clusief groenten, aardappelgerecht en 5 nagerechtjes. Eigenlijk net als in Alcazar dus… Bij een 4-gangen menu komt er ook nog soep bij. Alcazar
een













32 uur)
• met ruime ervaring (bij voorkeur opgedaan in een middelgrote organisatie) binnen de salarisadviespraktijk • met een afgeronde opleiding op MBO (bedrijfsadministratie) of MBO werk- en denkniveau aangevuld met PDL (Praktijk Diploma Loonadministratie)
• met goede mondelinge en schriftelijke vaardigheden
• met een representatief voorkomen en goede contactuele eigenschappen; je bent communicatief sterk, secuur, besluitvaardig, exibel, zelfstandig en gedreven
• met goede kennis van de Nederlandse taal
Wat je bij ons gaat doen…

• na een korte inwerkperiode, zelfstandig verzorgen van de gehele personeelsen salarisadministratie voor al onze cliënten in de breedste zin van het woord
• zelfstandig adviseren aan cliënten over de juiste toepassing van de cao afspraken en scale/sociale wet- en regelgeving en andere vakinhoudelijke vraagstukken

• het verzorgen van de meldingen, aangiften en mutaties aan externe instanties zoals pensioenfonds, uitkeringsinstanties, belastingdienst enz.

Mooi meegenomen vinden wij het als je ervaring hebt…
• met het salarispakket HR & Salaris Gemak van Exact
• met documenten beheer software Document Manager van Exact

• in het werken met Microsoft O ce 365 software
Wij stellen daar tegenover…
• een prettige collegiale informele werkomgeving met een exibele balans tussen werk en privé en een open werksfeer binnen de Hoeksche Waard
• een goed salaris afgestemd op opleiding, kennis en ervaring
• goede secundaire arbeidsvoorwaarden
Heb je jezelf herkend?
Mail of stuur dan snel je sollicitatie en C.V. naar: E aj.lems@lemslems.nl of Van Koetsveldlaan 15, 3273 AL Westmaas
Voor meer informatie raadpleeg onze website www.lemslems.nl.











Raamdecoratie: de mogelijkheden om te spelen met (zon)licht, om sfeer te creëren zijn (bijna) onbeperkt. Uni- of dessin in ontelbare kleurstellingen en materialen van aluminium, stof of PVC? Vult u maar in. Voor ieder interieur, voor iedere sfeer is er een oplossing. Vanzelfsprekend is de juiste functionele oplossing belangrijk. U weet wat u zoekt? Ga dan direct op uw doel af en bekijk onze uitgebreide mogelijkheden. U weet nog niet wat u zoekt? Geen probleem! Zonwering Hoekse Waard heeft met ABZ diverse uitgebreide eigentijdse collecties met verschillende functionele oplossingen. Kom naar onze showroom en doe inspiratie op! U bent van harte welkom!






















Kom naar de Aldenhuijsen open dag op 19 november!
Een bed moet niet alleen nu perfect voor u zijn, maar ook in de toekomst. Daarom is een bed van Aldenhuijsen altijd deelbaar, verrijdbaar en van alle gemakken voorzien. Met een praktisch bed vol gemak van Aldenhuijsen kunt u gemakkelijker uw bed opmaken, onder uw bed schoonmaken en prettiger in- en uitstappen.





Uniek voor een Aldenhuijsen is dat u uw Aldenhuijsen nog altijd later kunt uitbreiden met diverse functionaliteiten, zodat deze ook in de toekomst altijd bij u past.
De hele dag demo’s ontdek hoe u gemakkelijk uw bed kunt opmaken, eronder schoonmaakt en prettiger op de door u gewenste hoogte in- en uit kunt stappen
Gratis slaapscan met de Aldenhuijsen slaapscan ziet u hoe uw lichaamsbouw is en ontdekt u precies welke Aldenhuijsen bij u past
In het Aldenhuijsen Slaapadviescentrum maakt u op de open dag, onder het genot van een hapje en een drankje kennis met de nieuwe collectie van 2023. Ook worden er workshops gegeven, kunt u een gratis slaapscan van uw lichaam laten maken en gaat de eindejaarsverkoop van start. Bovendien profiteert u alleen op deze open dag van dubbele acties. Kom dus vooral langs op deze leuke én voordelige dag! Wij verwelkomen u graag.
Aldenhuijsen Slaapadviescentrum Rotterdam



Zaterdag 19 november van 09:30 uur - 17:00 uur Maasstadweg 100, 3079 DZ Rotterdam (gratis parkeren)
Maak kennis met de nieuwe collectie van 2023... ...en we vieren de start van de eindejaarsverkoop met extra korting!
Maak kennis met de allernieuwste collectie hoe u gemakkelijk uw bed kunt opmaken én schoonmaken
Alleen op deze dag dubbele actie bovenop € 500 zekerheidsvoordeel ontvangt u gratis in- en uitstapverlichting t.w.v € 249 bij aanschaf van een compleet nieuwe Aldenhuijsen
Aldenhuijsen, praktische bedden vol gemak www.aldenhuijsenslaapsystemen.nl e. contact@aldenhuijsenslaapsystemen.nl









































De koude maanden komen er weer aan, in huis wilt u het behaaglijk hebben, maar met de huidige energieprijzen is het tijd om eens te kijken naar isolerende materialen.
Heeft u al eens gedacht aan een overgordijn? Er komt veel kou van de ramen, een gesloten gordijn houdt deze kou voor een gedeelte tegen. Tegenwoordig hebben wij zelfs speciale thermosto en in ons assortiment. Denkt u nu dat zijn vast sto en die niet mooi hangen, goed nieuws, er zijn ook soepele thermosto en die mooi hangen.

Maak het geheel af met een passende plooi en railroede!
Vaak last van koude voeten? Denk dan eens na over de aanschaf van een karpet. Het voelt niet alleen comfortabel aan, maar zorgt ook voor warmte.
Wollen karpetten zorgen voor de beste warmte, maar er zijn ook zeker warme synthetische kwaliteiten.

Heeft u vloerverwarming maar mist u een karpet? Ook hier zijn zeker mogelijkheden voor, kom eens langs in de showroom dan kunnen wij u alles laten zien.






Op zoek naar een bijzondere vorm karpetten, ook hierin kunnen wij van alles leveren!










De Geus Tapijt in Puttershoek, uniek in de Hoeksche Waard.

Loop vrijblijvend binnen, u bent van harte welkom!

Arent van Lierstraat 16, Puttershoek Tel. 078 - 676 1359

Bezoek ook eens onze website: www.degeustapijt.nl
Openingstijden: Maandag t/m vrijdag van 9:00-17:00 uur. Zaterdag van 9:00-16:00 uur
Als snel na het einde van de Tweede Wereldoorlog kwamen via de zogenaamde legerdump achtergebleven vrachtwagens beschikbaar voor Nederlandse bedrijven. In zo’n 80 tot 85 % van de gevallen hebben we het dan over de legendarische GMC CCKW trucks. Vooral bij de aanleg van wegen, dijkversterkingen en ontelbare bouwprojecten zouden deze wagens met name als kippers een hele belangrijke rol spelen tijdens de wederopbouw.
Maar tegen het einde van de jaren vijftig dook in het straatbeeld een andere, grotere ex-leger truck, geschikt gemaakt voor civiele doeleinden op. Dat was de REO. Net als de GMC werd zijn werkterrein vooral het grondver zet en vervoer van zand. Rond 1960 doken ze steeds vaker op bij bouwen wegenbouw projecten. Zij aan zij met de GMC deden ze hun werk. Ook tal van Hoeksche Waardse aannemers hadden tussen 1959 en 1964 meerdere REO’s in hun wagenpark opgenomen: Onder meer Van Ruiven, Van der Linden, Barendregt en Naaktgeboren. De trucks hadden in eerste instantie vaak nog de originele, hoekige fabriekscabine, maar werden al vrij snel voorzien van een moder nere cabine, vaak gemaakt door de firma v. Eck. De bijdrage die de REO kippers leverden aan de periode van wederopbouw van ons land is dus beperkt, want rond 1960 was die al grotendeels achter de rug. Maar de trucks hebben wel degelijk
een belangrijke rol gespeeld bij de snelle economische groei, die begin jaren zestig was begonnen. Ze waren niet zo talrijk voorradig als de GMC’s, maar ze waren groter en zwaarder en konden als kipper dus meer vracht vervoeren. En ze waren een uitkomst voor de aannemers die nog geen nieuwe Henschels, DAF of Mercedes kip pers aan konden schaffen.
De M35 was een vrachtwagenfami lie ontwikkeld door REO Motor Car Company voor de United States Army. De vrachtwagen valt in de 2,5 ton gewichtsklasse. Hoewel de basis M35 vrachtwagen ontwik keld was om 2.300 kg offroad en 4.500 kg op de weg te vervoeren zijn er situaties bekend waarbij er tweemaal zo veel vervoerd werd. Net als de GMC gingen ze dus weleens overbeladen de weg op. De M35 vormde de basis voor een hele serie gespecialiseerde voertuigen. Na het einde van de Tweede Wereldoorlog was de zoektocht naar de opvolger van ‘Jimmy’, de bekende GMC CCKW 2,5 tons vrachtwagen begonnen.

De vrachtwagenfabrikant Reo Motor Car Company en de Truck and Bus Division of General Mo tors, deze laatste was de grootste Amerikaanse producent van de bekende 2,5 tons vrachtwagen in de jaren 1940-1945, ontwikkelden een nieuwe 2,5 tons vrachtwagen; de M34. Deze vrachtwagen had aandrijving op alle zes de wielen (6x6) en de achterwielen stonden eerst op enkele banden. Op basis van het ontwerp kreeg Reo een order voor 5.000 exemplaren en de eerste vrachtwagens werden in 1950 geleverd. (In totaal werden er zo’n 150.000 gebouwd.) Veel van de civiele REO kippers die in ons

land aan het gingen werk waren oorspronkelijk de M35 legertrucks.

GINAF en Terberg
Twee bedrijven speelden een be langrijke rol bij het ombouwen van REO’s naar civiele trucks: GINAF en Terberg (Terberg-Benschop).
Hoewel zij zich eerst vooral ook richten op kippers, bouwden zij de REO vrachtwagens ook om naar speciale trucks, zoals (voor die tijd) zware takelwagens. In 1959 had GINAF (familiebedrijf van drie broers Van Ginkel) een grote partij dump onderdelen en REO’s gekocht. Deze REO’s hadden een wagenmakerscabine. De klant kon
zelf het merk motor kiezen. Met DAF componenten werden echter de meest positieve ervaringen opgedaan. Terberg (Terberg-Ben schop) is een Nederlands vracht automerk gevestigd in Benschop. Het familiebedrijf is tegenwoordig leverancier van specialistische industriële voertuigen. In 1966 produceerde Terberg zijn eerste eigen trucks, een REO-basis met Mercedes-Benz-componenten. Een jaar later kwam men met een nieuwe truck met DAF-motor en een Van Eck-cabine. Geleidelijk werd vervolgens begonnen met ex pansie en export. Beide bedrijven bestaan nog steeds.



























Na de Watersnoodramp van 1953 werd in opdracht van het Commissariaat voor Sociale en Culturele Arbeid onderzocht welke projecten op het gebied van maatschappelijk-, vormings- en jeugdwerk aandacht behoefden. Onderdeel van de rapportage van destijds vormde een gedetailleerd beeld van de dorpen in Hoeksche Waard. De artikelen uit deze serie zijn een samenvatting van het werk van de rapporteurs. Deze keer in deel 2: Zuid-Beijerland in 1953.
Henk van den HeuvelNa de bedijking van de polder Groot Zuid-Beijerland in 1631 begon dit dorp, ontstaan uit enige woningen nabij een sluis, zijn ontwikkeling. Het dorp ligt vrij geïsoleerd en heeft geen eigenlijke kern; het is een lan ge reeks huizen ter weerszijde van de dijk. De woningtoestanden zijn slecht met de bekende gevolgen. De bevolking is eenvoudig, er zijn veel landarbeiders. Weinig boeren en fabrieksarbeiders vergeleken met de meer oostelijk gelegen plaatsen. Van de boeren is de helft pachtboer en de helft eigenaar. Het verschil eigenaar - pachtboer betekent hier geen standsverschil. De eigenaren van de verpachte gronden waren vroeger veelal de grote heren uit Dordrecht, thans vindt men ze in geheel Nederland. “Cromstrijen” is nu een landbouw-grootbedrijf, waar tweehonderd arbeiders wer ken; de aandelen zijn in verschillen de handen. Er worden veel klachten gehoord over nervositeit en ver moeidheid. Houdingsafwijkingen en platvoeten komen veel voor, zoals ook vermeld in de rapporten van de schoolartsendienst. Zeker is, dat de aard van de arbeid, grof schoeisel en bepaalde voedingsgewoonten hier een rol spelen.
De Openbare Lagere School (OLS) heeft momenteel honderdtwintig
leerlingen, de Christelijke Lagere School (CLS) honderdtweeënnegen tig. De verhouding tussen de scho len is goed. Veel arbeiderszoons gaan na de LS naar de Lagere Land bouwschool in Klaaswaal. Van de boerenzoons gaan er jaarlijks zes á zeven naar de Rijkslandbouwwin terschool in Dordrecht. De jongere boerenzoons gaan dikwijls naar de H.B.S., omdat zij niet op de boer derij zullen komen. De CLS heeft een oud-leerlingen-vereniging, die lezingen en films organiseert.
De Gereformeerde Gemeente te Zuid Beijerland is in 1950 geïnsti



tueerd. Samen met de Gerefor meerde Gemeente van Klaaswaal (waar men vóór 1950 kerkte), telde men 99 leden en 160 doopleden. Omtrent de kerkelijke toestanden vertelt men, dat deze omstreeks 1860 slecht waren. Het leven van de predikant strekte niet tot voor beeld, en ook was er, zoals men dat noemde, “moderne prediking”. Omstreeks 1860 kreeg de bekende dominee H.J. Budding hier grote invloed. Hij predikte ook meerma len hier en trok veel mensen in de gezelschappen. De toenmalige pre dikant in de Gereformeerde Ker ken keerde zich tegen Budding en zijn invloed. In 1900 kwam er een confessionele predikant die grote invloed had en een goede kern opbouwde, die nu nog werkzaam is. De verhouding gereformeer den-hervormden werd toen ook beter. De boerenstand is liberaal, doch niet vrijzinnig. Het zijn niet de trouwste kerkleden; uit deze
gen ingediend, vermeldde onlangs 3 gereformeerden als de eerste drie kandidaten. Blijkbaar zijn dus voornamelijk de gereformeerde kerkleden op de A.R. georiënteerd. Er is een oplevende propaganda-ac tiviteit voor Christelijk Historisch (C.H.U.). Nieuwendijk en een kern in het dorp stemmen S.G.P., de boe ren over het algemeen V.V.D. Zoals blijkt, neemt de P.v.d.A. zeer toe.
Het eiland Tiengemeten telt on geveer 175 inwoners, waarvan er een 140-tal tot de gemeente ZuidBeijerland behoren. Het eiland bestaat uit een 9-tal polders met een oppervlakte van 700 hectare en verder ruim 300 hectare bui tenlanden. Door de zeer afgelegen positie van dit eiland, dat zelf geen kerk heeft, komen weinigen naar de kerk in de Hoekse Waard. De kerk betaalt de veerman voor de overtocht op Zondagmorgen. Men denkt hier vaak zeer liberaal over de kerk: ”Ze is nuttig, want ze spaart politie uit.”
ontbreekt het aan de mensen met voldoende tijd en inzicht. Er zijn slechts enkele doorzetters, door wie bijvoorbeeld de padvinderij opgezet werd. De jeugd gaat vrij veel naar het dichtbij gelegen Klaaswaal. Toen de burgemeester daar verordende dat de cafés om tien uur gesloten moesten zijn, kwam men nog later thuis, omdat men dan na tienen nog even in Numansdorp ging kijken. Er is een muziekvereniging “Crescendo” met 30 leden, een zangvereniging “Hosanna” met 25 leden en een Mondaccordeonvereniging “Bravo”, die voor het merendeel uit landar beiders bestaat.
In 1947 richtte men een korfbalclub op. Deze nam in aantal leden af, toen er een voetbalclub en een gymnastiekvereni ging bijkwamen. De voetbalvereniging “Hercules” telt 60 leden en speelt op Zaterdagmiddag. Uitgaande van een afdeling van Volksonderwijs was er een toneel groepje, dameskoor, breiclub en een reisclub. En er is een afdeling van de padvinderij. Deze neemt niet zozeer toe in ledental, maar wat er is, gaat goed. Zowel kinderen van gerefor meerde als van hervormde ouders nemen er aan deel. De clubs tellen thans 24 kabouters en 12 welpen.
De Jonge Kerk in Zuid Beijerland, met enthousiasme na de oorlog begonnen met een groep, is nu op geen enkele wijze actief meer. Er is in het dorp geen goede lokaliteit waar men vergaderen kan. Ook het café beschikt niet over een geschikte zaal. Een zaaltje van de diaconie verkeert in zeer vervallen toestand; een andere lokaliteit „Ons Huis”, is totaal ongeschikt. Voor de watersnood was er een tekening en een begroting voor een jeugdge bouw. Men onderneemt acties ten bate van het “jeugd-gebouwfonds” en heeft reeds een aardig bedrag bijeen, dat echter nog veel te klein is om de plannen te verwezenlijken.
stand komen dan ook bijna geen kerkeraadsleden. De kerkeraad bestaat voornamelijk uit midden standers; deze groep bezoekt over het geheel de kerk het trouwst. Het kerkbezoek loopt de laatste jaren enigszins terug. Opmerkelijk is, dat bij de biddag voor het gewas ook de buitenkerkelijke boeren komen.
De Anti Revolutionaire Partij ver liest haar hervormde leden. De lijst, voor de gemeenteraadsverkiezin
Het verenigingsleven heeft een moeilijk bestaan. Samen werken, zich gezamenlijk ergens voor inspannen blijkt niet gemakkelijk te kunnen. Dit moge blijken uit het feit, dat men niet kan komen tot een gezamenlijk jeugdgebouw en tot een betere kleuterschool. Spre kers van buitenaf trekken weinig belangstelling. Eenmaal heeft zo’n spreker zijn causerie gestaakt, omdat hij met pepermuntjes gegooid werd. Voor het jeugdwerk
Volgende keer in deel 3: Puttershoek
De volledige rapportage waarop dit artikel is geba seerd kunt u raadplegen op internet via het webadres: piershil.com/category/1953
De aard van de arbeid, grof schoeisel en bepaalde voedingsgewoonten spelen hier een rol
De kerk is nuttig, want ze spaart politie uit













Vanaf vandaag kunnen klanten zich online aanmelden voor de nieuwe Jeep Avenger 1st Edition, een zeer compleet uitgeruste en in oplage gelimiteerde versie die verkrijgbaar is vanaf €40.500,-.
De compacte Avenger is het eerste model van Jeeps nieuwe gamma van volledig elektrische SUV’s met op de Europese markt afgestemde afmetingen. Het is ook het eerste
nieuwe model in Jeeps wereldwijde elektrificatiestrategie. Jeep wil we reldwijd hét toonaangevende merk worden voor emissievrije SUV’s.

De Avenger is vanaf het begin vol ledig als een echte Jeep ontworpen en ontwikkeld. De compacte SUV
heeft dan ook nadrukkelijk het DNA van Jeep. De SUV biedt een unieke combinatie van (terrein) capaciteiten, stijl, functionaliteit en verfijnde technologie en speelt in op de behoeften van mensen die ook hoge eisen stellen aan connec tiviteitsmogelijkheden.
De Jeep Avenger loopt van de band in de Stellantis-fabriek in Tychy, Polen. Jeep voorziet de auto standaard van Selec Terrain en Hill Descent Control. Met deze systemen staat de Avenger met zijn grote aanrij- en afrijhoeken en riante bodemvrijheid garant voor indrukwekkende terreinvaardig heid. Jeep ontwikkelde de Aven ger met het oog op de specifieke behoeften van de Europese klant. De compacte SUV past met een lengte van vier meter in het snel groeiende B-SUV-segment. Dat is
op basis van verkoopvolume het op één na grootste segment van Europa. Naar verwachting bereikt het B-SUV-segment in 2023 een jaarlijks verkoopaantal van 2,2 miljoen auto’s, ofwel een vijfde van het totale aantal verkochte auto’s in Europa. De Avenger komt direct onder de Jeep Renegade, die ook in het B-SUV-segment valt.
“De Jeep Avenger is onze eerste emissievrije SUV”, zegt Antonella Bruno, Head of Jeep Europe bin nen Stellantis. “Het is het nieuwe instapmodel van ons gamma en maakt daarmee ons aanbod in de SUV-markt compleet. We verwach ten dat de Avenger in 2024 ons bestverkopende model zal zijn. De Avenger voegt een nieuw niveau van elektrificatie toe aan ons aan bod en markeert de volgende stap in de evolutie van het merk Jeep.









De auto is emotioneel en trendy, biedt plezier en onderscheidt zich.”
De Jeep Avenger verschijnt begin volgend jaar in de showrooms en is gericht op mensen met een actieve lifestyle die een veelzijdige SUV zoeken met een modern design, compacte afmetingen en een ruim interieur.
Geheel nieuwe, volledig elektrische aandrijflijn Jeep rust de Avenger uit met een elektrische aandrijflijn van de volgende generatie, die een nieuwe elektromotor en een nieuw ac cupakket omvat. Dankzij het hoge vermogen en de grote trekkracht van de motor in combinatie met de specifiek afgestemde aandrijflijn biedt de Avenger compromisloos rijplezier, zowel op gebaande wegen als daarbuiten.
















ware maakt over-the-air updates (OTA) mogelijk. Zo blijft het ener giemanagement van de EQE SUV gedurende de gehele levenscyclus up-to-date.







De huidige generatie rijassistentie systemen omvat tal van functies die de bestuurder ondersteunen. Tot de standaarduitrusting van de EQE SUV behoren onder andere AT TENTION ASSIST, actieve remas sistent, actieve spoorassistent, parkeerpakket met achteruitrijca mera en snelheidslimietassistent.
De status en de activiteiten van de systemen worden schermvullend weergegeven op het assistentiedis play in het bestuurdersdisplay. Andere opties zijn beschikbaar in het assistentiepakket en in het rijassistentiepakket plus.

baande paden. Achterasbesturing met een maximale stuurhoek van 10° is als optie leverbaar.
De EQE SUV biedt de mogelijkheid om via over-the-air technologie (OTA) op een aantal functionele gebieden extra voertuigfuncties te activeren. Dit betekent dat na aankoop en na keuze van de oorspronkelijke configuratie veel uitrustingen van de EQE SUV indi vidueel kunnen worden aangepast. De OTA-functies zijn beschikbaar in de Mercedes me Store en het aanbod zal steeds verder worden uitgebreid.

De EQE SUV is een van de ruimste voertuigen in zijn segment. Toch is hij compacter dan de EQE Limousine en
heeft hij met 3.030 mm een 9 cm korter wielbasis. De exterieur afmetingen zijn 4.863/1.940/1.686 mm (lengte/breedte/hoogte). Als vierde model na de EQS en EQE
Limousines en de EQS SUV maakt de EQE SUV gebruik van het nieuwe volledig elektroplatform
Een actieradius tot 590 km2 De EQE SUV biedt, dankzij het modulaire aandrijfconcept, een breed scala aan vermogensuit voeringen, van 215 kW/292 pk tot 300 kW/408 pk. Afhankelijk van de uitrusting en de configuratie bie den de Europese uitvoeringen een WLTP-actieradius tot 590 km. De lithium-ion-accu van de EQE SUV bestaat uit tien modules.

De innovatieve, in eigen huis ontwikkelde accumanagementsoft
Het onderstel van de nieuwe EQE SUV bevat een vooras met vier draagarmen en een onafhankelijke multilink achteras. Dankzij de relatief korte wielbasis van 3.030 mm en de bijbehorende onderstel afstemming voelt hij ook in de ba sisuitvoering bijzonder wendbaar en dynamisch aan. De luchtvering AIRMATIC met traploos verstel bare demping ADS+ is als optie leverbaar. Om de bodemvrijheid te vergroten, kan het voertuigniveau met maximaal 30 mm worden ver hoogd. Naast de DYNAMIC SELECTrijprogramma’s ‘ECO’, ‘Comfort’, ‘Sport’ en ‘Individual’ beschikken de EQE SUV-modellen met 4MATIC ook over het rijprogramma ‘Off road’ voor rijden buiten de ge
Het weergave- en bedienings concept MBUX doet, met behulp van adaptieve software, geper sonaliseerde suggesties voor tal van infotainment-, comfort- en voertuigfuncties. Een highlight in het interieur is het optionele MBUX Hyperscreen. Dankzij het zerolayer design hoeft de gebruiker niet door submenu’s te scrollen of spraakopdrachten te geven. Situatieafhankelijke en contextuele toepassingen worden bovenaan in het gezichtsveld aangeboden. Bij het MBUX Hyperscreen (optie) lopen drie displays bijna naadloos in elkaar over tot een widescreen van ruim 141 cm breed.


















